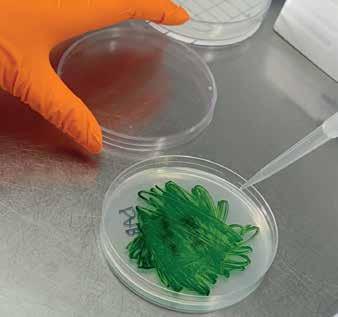

pesquisafapesp



by
Organisms that live for only one day can predict seasonal changes
Brazilian blend
DNA sequencing reveals Indigenous, European, and African ancestry and could democratize access to personalized health care

A prototype device for breast exams does not compress the breast or use X-rays
Elite soccer players are characterized by planning ability and mental versatility
Gas emitted
Amazonian trees accelerates cloud formation
The significance of populational diversity
ALEXANDRA OZORIO DE ALMEIDA Editor in Chief
When the major human genome sequencing projects began in the late 20th century, the belief was that the differences in the genetic composition of different individuals would be minimal. Therefore, to reach the goal of a complete reference genome, little attention was paid to the populational diversity in the samples to be sequenced. It turned out that humans have far fewer genes than expected and that they are not the key to the differences between individuals. Technological advances have made it possible to identify millions of minor changes to the genome—variations that can alter the form and function of proteins or the pattern of activation/deactivation of the genes that they encode. They can be common to populations and have important consequences for public health, such as the propensity to develop a certain disease or how different organisms react to certain medications.
An article published in Science last May sequenced the genomes of 2.7 thousand people from all parts of Brazil. Not only do the results allow a deeper understanding of the genetic diversity of the population, but they also support Brazilian efforts toward precision medicine and its availability in the national health system ( page 6 ).
Genetic diversity is also at the heart of another feature, but the subject is cassava, not human genes. Certain cultivation practices used by indigenous peoples such as the Waurá are important for the maintenance of genetic varieties and for guaranteeing food security ( page 37). This edition also offers a diversity of themes, such as research revisiting the works of Jorge Amado (1912-2001), one of the best-known Brazilian writers abroad ( page 58). The technology section offers views from above: nanosatellites for locating shipwrecks
( page 57) and radar-equipped drones that can monitor crops or scan for anthills or buried skeletal remains ( page 40).
The May edition of Pesquisa FAPESP in Portuguese featured an interview with the philosopher Luiz Henrique Lopes dos Santos of the University of São Paulo. A researcher in the field of logic, Lopes dos Santos has a long track record as an advisor to the Scientific Directorate of FAPESP, the São Paulo Research Foundation. He helped create various research programs, and for 21 years, he was the scientific coordinator of this magazine. It is difficult to summarize his importance in the construction of this publication’s identity. Shortly after granting this interview, Lopes dos Santos was diagnosed with cancer; he passed away last July. His legacy in our newsroom is the daily quest for quality writing combined with scientific accuracy, with a view to engaging a wider audience ( page 16 ).
As we prepare this edition for print, COP30 is taking place in Brazil for the first time. Covering the science behind climate change has always been a staple part of our work. One example is the feature on research that highlights the importance of aerosols, a type of particle, in cloud formation ( page 44). It has been known for some time that aerosols accumulate over the Amazon rainforest. A recent study revealed that isoprene, a gas emitted by trees as a thermal regulatory mechanism, accelerates the formation of these particles, which can travel thousands of kilometers and become cloud seeds.
This international edition features a selection of articles originally published in Portuguese between January and June 2025. New content in English is published monthly on our website (revistapesquisa.fapesp.br/en/).
revistapesquisa fapesp

COVER A series of portraits by photographer Luiz Braga , from Pará, illustrates this issue’s cover and cover features. A retrospective of his 50 years capturing the faces of people from the Amazon was exhibited at the Moreira Salles Institute, São Paulo, in 2025
5 LETTER FROM THE EDITOR
COVER
6 Sequencing of the DNA of 2,723 Brazilians sheds new light on the country’s mixed ancestry
12 Genome information could pave the way to personalized medicine for all
INTERVIEW
16 Philosopher
Luiz Henrique Lopes dos Santos revisited his academic career and discussed the more than 30 years he devoted to FAPESP
INNOVATION
22 Study details how university laboratories forge partnerships with industry
December 2025

PSYCHOLOGY
26 Elite soccer players have good memories and mental versatility
PHYSIOLOGY
30 Blood vessels release compounds that modulate heart rate and blood pressure
CHRONOBIOLOGY
34 Although cyanobacteria live only for one day, they pave the way for seasonal changes
AGRICULTURE
37 Planting techniques used by the Waurá people in the Upper Xingu region increased the genetic diversity of cassava
AGRONOMY
40 Drone radar monitors crops and locates ant nests and bones underground
ATMOSPHERIC CHEMISTRY
44 Gas emitted by trees in the Amazon accelerates cloud formation

CLIMATE CHANGE
48 Extreme events combining heatwaves, acidification, and chlorophyll shortages have ravaged the South Atlantic
PHYSICS
51 The study of the interaction between light waves and mechanical waves could lead to advances in the field of quantum information
HEALTH
54 New breast exam device dispenses with the need for compression and radiation
AEROSPACE ENGINEERING
57 Brazilian nanosatellite has been designed to locate shipwreck survivors
LITERATURE
58 Researchers revisit the work of writer Jorge Amado
MUSIC
62 Studies uncover rarities and expand access to little-known music collections
66 PHOTOLAB

European father, African or Indigenous mother
DNA sequencing of 2,723 Brazilians reveals a violent legacy behind the interracial mixing that shaped the Brazilian people
GUIMARÃES photos LUIZ BRAGA
MARIA

Unsurprisingly, Brazilian people have a mixed racial background, but the details of how this story unfolded and its consequences are only gradually being revealed by geneticists and historians. The latest study, which was published in the scientific journal Science in May, deepened and expanded our knowledge of Brazilians using the DNA sequencing of 2,723 people from across the country. The results reveal strong African and Indigenous ancestry in the maternal lineage, the legacy of widespread violence against women, and an unexpected number of unknown genetic variants with potential health consequences.
“It is really amazing to see in DNA what we already knew from history books,” says geneticist Lygia da Veiga Pereira of the Institute of Biosciences at the University of São Paulo (IB-USP), creator of the “DNA do Brasil” project, which aims to paint a genomic portrait of the Brazilian population by sequencing complete samples collected from all over the country. According to Pereira, until approximately 10 years ago, the genetic diversity of human population samples was very low, around 80% from European ancestry, because most stud-
ies were carried out in the Northern Hemisphere. In Brazil, the focus was on the southern and southeastern regions, where a lower presence of African and Indigenous ancestry was found. Investments in expanding this perspective led to the Genomas Brasil Program at the Ministry of Health’s Department of Science and Technology (DECIT) at the end of 2019, —although the COVID-19 pandemic, which started just a few months later, put a halt to activities for almost two years.
Pereira began to take an interest in the genetic diversity of the population when she realized, approximately 20 years ago, that the discarded embryos from assisted reproduction clinics in São Paulo that she used for her stem cell research were of 90% European ancestry. Those data were not representative of Brazil’s makeup as a whole; it rather reflected the users of those private services. Meanwhile, geneticist Sérgio Pena of the Federal University of Minas Gerais (UFMG) was studying the DNA of Brazilians from various regions using the tools available at the time, which were much more limited than those in use today. In 2000, he published the results of an analysis of 200 samples from white people in Ciência Hoje and the American Journal of Human Genetics.
Interracial mixing in history
Violence in the formation of the Brazilian people left marks on the genome
1500
On their arrival, Europeans found a population of around 10 million Indigenous people, which was later decimated; sexual violence against women was the norm from the start
17th Century
Genetic markers from 16 generations ago show evidence of mixing between Indigenous women and European men
18th Century
The diamond mining period, which was almost 12 generations ago, brought a large influx of Europeans to Brazil; trafficking of slaves from Africa increased tenfold
Early 19th century
Before the end of the slave trade, around two million slaves were brought over from Africa in the 19th century; eight generations ago was the period of greatest mixing between men of European ancestry and women of African descent
1822 – Independence
Marriages between freed slaves and Europeans were encouraged as a “civilizing” strategy: there was talk of Europeanizing the mixed-race population
1850
Slave trafficking was prohibited 1871
The Law of Free Birth allowed children to be exploited up until the age of 21 but made it illegal for them to be sold. With the loss of market value, slave masters no longer had an interest in having children with enslaved women, and thus interracial mixing declined
1888
Slavery was abolished
Late 19th century, early 20th century
The Brazilian government encouraged the immigration of White men, especially Italians, Germans, Spanish, and Portuguese. The arrival of some four million Europeans is detectable in the genetic makeup
21st century
Most marriages are now between people of similar ancestries

Three in five had Indigenous or African maternal heritage, which was more than expected. The study was reported on by Pesquisa FAPESP in just its second year.
Pena continued to study the topic in more depth and joined forces with another group that was pioneering the study of Brazilian DNA, under the leadership of geneticist Francisco Salzano (1928–2018) of the Federal University of Rio Grande do Sul (UFRGS). Through research led by Maria Cátira Bortolini, which included Tábita Hünemeier's master's degree, the two groups from Minas Gerais and Rio Grande do Sul realized that the African contribution was much broader than indicated by historical records on slavery, which were highly concentrated in Angola, on the west coast of the continent. The western region, where Senegal and Nigeria are located, also made a significant genetic contribution—more in São Paulo than in Rio de Janeiro, indicating asymmetries in the slave trade, according to an article published in the American Journal of Biological Anthropology in 2007. “There is no other country in the world with as much interracial mixing as Brazil,” Pena said in an interview in 2021.

The technology has since evolved significantly, leading to a new article published in Science. The paper reveals that European heritage accounts for approximately 60%, whereas African ancestry contributes 27% and Indigenous ancestry represents 13%, in addition to the sexual asymmetry noted by Pena: the paternal lineage, expressed on the Y chromosome present only in men, is predominantly (71%) European. Moreover, the DNA of the mitochondria—the part of the cells passed down only from the mother—comprises 42% African ancestry and 35% Indigenous ancestry.
“The only explanation is four centuries of various forms of violence,” summarizes Hünemeier, currently a professor at IB-USP and one of the leaders of the research. She notes that it is not uncommon to hear older people say things such as “my grandmother was caught by the lasso,” without thinking about what this statement actually means. In more recent generations, marriage between similar ancestries has become more common. According to Hünemeier, the results help debunk the myth of racial democracy that is so often cited as part of the Brazilian identity, since interracial mixing was often something that occurred without consent.
“Brazil needs to reexamine its history and stop saying that we are a country of voluntary interracial harmony,” adds USP historian Maria
Helena Machado, who did not participate in the study. “Our mother is African, our grandmother is Indigenous, and our grandfather is a European who had illegitimate children with her out of wedlock.” Machado is an expert in gender and motherhood during slavery, a system that spanned the entire colonial period and the empire. In 2024, she published the book Geminiana e seus filhos: Escravidão, maternidade e morte no Brasil do século XIX (Gemini and her children: Slavery, motherhood, and death in nineteenth century Brazil; Bazar do Tempo) in partnership with historian Antonio Alexandre Cardoso of the Federal University of Maranhão. “Enslaved women—Indigenous or African—were at the service of their enslavers, making harassment and rape commonplace,” he states.
Women were thus doubly enslaved—forced into being workers and reproducers. “The very bodies of enslaved women were colonized,” Machado explained that Portuguese colonial policies and the policies of Brazil as an independent country from 1822 onwards always encouraged racial mixing and whitening. For example, in 1823, as a member of the constituent assembly, José Bonifácio de Andrada e Silva (1763–1838) argued for the formation of Brazilian people through marriages between White men and Afro-descendant or Indigenous women. This approach was part
of a “civilizing” project in which the Black population would be integrated into the European population. With slavery continuing until 1888, however, enslaved women remained subject to those who had control over their bodies. “All of this led to the situation that geneticists now describe,” Machado concludes.
The wide diversity of African ethnicities, as Hünemeier has noticed since the beginning of her scientific career, is also interesting. People who would never have met in Africa because they lived in countries and communities separated by great distances were forcibly placed on the same slave ships and grouped together in slave labor. The objective was to group people from different cultures who did not even speak the same language to minimize the risk of them organizing to fight back against their “masters.” The result is an amalgamation of an entire continent, which can only be found in Brazil. “It is the country with the most African ancestry outside of Africa,” says the geneticist.
In addition to the initial influx of Portuguese from the sixteenth century onwards, European diversity is also high, with a significant flow of immigrants from Germany and Italy in the nineteenth and twentieth centuries, as well as from other countries in lower amounts. One interesting data point was 10 individuals of Japanese descent sampled in São Paulo who showed no signs of interracial mixing, thus revealing a highly restricted and recent contribution to the genetic makeup of the national population.
This article describes the colonization of the Americas as the largest population displacement
Regional ancestry
in human history. In Brazil, some five million Europeans and five million Africans were transplanted to the region, which until then was populated by roughly 10 million Indigenous people who spoke more than 1,000 different languages. These peoples were decimated, suffering a population decline of 83% in the interior of the country and 98% on the coastline between the year 1500 and the present day.
“We expected to find new genetic variants, but the results went far beyond that,” says geneticist Kelly Nunes, who analyzed the data during her postdoctoral fellowship in Hünemeier’s laboratory at IB-USP, alongside three other colleagues with whom she shares the position of lead author of the article: Marcos Castro e Silva, Maira Ribeiro, and Renan Lemes. Variants are differences in a person's sequence relative to the reference genome. “We detected 78 million variants, of which almost nine million were not recorded in any other database.” It became clear that the DNA of the Brazilian population includes a sample of populations that have been neglected from a genomic point of view, especially Africans and Indigenous South Americans. In the near future, with more sampling, it will be possible to better determine the scale of this source of genetic novelties. “We established partnerships to obtain samples from all five Brazilian regions, which gave us greater access to African and Indigenous ancestry,” explains the researcher.
Approximately 36,000 of the nine million new variants described appear to have harmful effects by generating anomalies in their respective proteins, such as loss of function, and may be associated with diseases such as cancer, metabolic dysfunction, or infectious diseases. “What we discover about these variants can be extrapolated
The northeast of the country has more African areas, whereas the southeast and south are more European, and Indigenous heritage is more concentrated in the north

AFRICAN INDIGENOUS EUROPEAN

to peoples that have not been sampled, such as those on the African continent,” proposes Nunes. Knowledge of ancestry and how propensities for certain diseases are distributed across the genome and populations of the world can help make access to precision health more equal, as detailed in the article that follows this one on page 12.
When analyzing genes with signs that they were favored by natural selection (those that occur more frequently than would be expected randomly), many of those genes identified were linked to fertility or the number of children generated, with European ancestral origins. This trait clearly had benefits during the colonization process, during which the Portuguese who settled here quickly increased their presence. Immune response genes of African origin also showed signs of natural selection, reflecting the history of a broad range of pathogens.
The results also offer genetic clues concerning metabolic diseases concentrated in Indigenous ancestry, which are apparently linked to gradual changes in eating habits. “We started eating processed foods, which creates an environment of natural selection for certain genes,” explains Nunes.
One of the study’s challenges was the data analysis, which relied on cloud computing infrastructure provided by Google. “In Brazil, there were no professionals qualified to deal with this volume of information,” says the geneticist, who claims to have learned a lot from the project, which also trained many other people. Another 7,000 genomes have already been sequenced, expanding the search for representation. The authors promise there will be new results soon. Similar initiatives in other countries in the region could also contribute to our understanding of South American history. “We detected a specific component of pre-Columbian genetic ancestry, present mainly in central-western Argentina,” Argentine geneticist Rolando González-José, a researcher at the Patagonian National Center (CENPAT) and head of the Argentine Population Genome Reference and Biobank Program (POBLAR), who is not a participant of the USP project, told Pesquisa FAPESP by email. “Long-held assumptions about population dynamics in the post-contact period do not sufficiently explain the evolutionary history underlying genetic diversity in modern Argentine populations.” Collaborations with Brazilian scientists, in his opinion, can bear fruit. l
The research project, scientific articles, and book consulted for this report are listed in the online version.
Precision for all
Genome information about the Brazilian population could democratize access to personalized treatments and reduce national health care costs
Precision medicine was born out of human genome sequencing and is not a luxury—on the contrary, it enables more accurate diagnoses of some diseases and better and safer medication planning. It is good for the health care system, helping reduce wastage of resources on ineffective procedures, and it is good for patients, who receive the treatment that works best for them, with fewer side effects. However, Brazil suffers from a shortage of the biological parameters needed to know which genetic variants cause which diseases in the country because the sequences used as international references were mostly obtained from people of European descent in the Northern Hemisphere.
The focus on local and regional diversity is not parochialism. Although most of the genome is common to all people, specific modifications can make a significant difference in how genes function, and if defective, they can cause diseases). It is therefore crucial to understand the genetic composition of the Brazilian population, which is why the Department of Science and Technology (DECIT) at Brazil’s Ministry of Health is now creating the National Genome and Precision Medicine Program: Genomas Brasil. In addition to examining Brazilian DNA (see
report on page 6), it encompasses other projects, including Genomas SUS, through which several universities are evaluating the impact of the genome on health.
Started in April 2024, the project aims to sequence the complete genomes of 21,000 Brazilians by November. The goal is to reach 80,000 genomes over the next three years, ensuring the ability to sample a high diversity of ancestries. Additionally, FAPESP has announced a call for proposals to fund the sequencing of an additional 15,000 samples. The aim is to select smaller projects from among scientists who are not currently participating in Genomas SUS. “The foundation will provide a counterpart to the national research,” explains Dr. Leandro Machado Colli of the Ribeirão Preto School of Medicine at the University of São Paulo (FMRP-USP), coordinator of the project. “Samples can be collected anywhere in Brazil, as long as the researchers are based in São Paulo.”
He explains that the strategy adopted by Genomas SUS is to use short-read sequencing, which involves reading the genome from short sections of 150 base pairs, a more cost-effective method. With more complete sequencing to ensure context, the benefits are tangible. “Of the 21,000 samples we already have, we will sequence 200 using long-read technology as a more accurate

MARIA GUIMARÃES photos LUIZ BRAGA

point of reference,” says the researcher. Longread sequencing uses larger sections containing hundreds of thousands of base pairs. In the effort to identify genes linked to diseases, determining the ancestry of each section of the patient's DNA is essential. “We will then know what a certain piece of genetic material in a certain geographic location might say about a person’s health.” The reason is that with sequencing—even the least precise form—it is possible to identify the locations of altered variants on each chromosome and to potentially link them to a propensity for diseases associated with them.
To ensure that the diversity born from interracial mixing is properly represented, Genomas SUS has nine anchor centers across the country: two of them are in São Paulo, and the others are in Rio de Janeiro, Minas Gerais, Paraná, Pernambuco, and Pará. “The Brazilian population has a large representation of peoples who mixed during the country’s formation, including people of Indigenous and African ancestry,” says geneticist Ândrea Ribeiro-dos-Santos, head of the only center in the North region, which is based at the Federal University of Pará and opened in September 2024. “In the Amazon region, Indigenous women were often welcomed into quilombola communities because they knew the secrets and ways of living in the forest,” he explains, based on research results from his group, which identified the sexual asymmetry in genetic contributions.
Just like the center in the Northeast, the Amazon region’s center does not yet have its own sequencing device; thus, the DNA molecules that it collects must be sent for analysis at other centers. To date, 1,800 samples have been sequenced, most of which are from Pará. However, this should change with the inclusion of other states in the region. “Two weeks ago, we were on a health mission in Amapá, where we collected samples in partnership with the state and municipal health departments and the Federal University of Amapá.” Agreements with institutions in Amazonas and Acre are under negotiation, seeking to comply with mandatory ethics issues. The challenges in the region are significant: it can take days to reach some traditional communities, with travel by plane and car followed by days on a boat. However, it is in these remote locations that a unique wealth of the Brazilian territory is found: the genetic and cultural diversity of its human population.
Ribeiro-dos-Santos highlights the importance to the Brazilian national health system (SUS) of

understanding regional or rare genetic variants so that the system can implement treatment protocols for diseases such as diabetes and cancer. There is usually no single gene behind these diseases but a multitude of pathways that can cause dysfunctions in cell replication, leading to cancer, or in metabolism in the case of diabetes, and any altered part can trigger the disease. A successful medication is one that affects the root of the problem. “Without specific knowledge, the patient may die as a result of the treatment, or it may have no effect at all.”
“It is important to know how we can use the genome to understand social inequalities and better diagnose complex genetic diseases,” adds biologist Eduardo Tarazona of the Federal University of Minas Gerais (UFMG), head of the National Institute of Science and Technology - Genome Ancestry, Diseases, and Bioinformatics in Brazil (INCT-AncesGen) and one of the researchers leading Genomas SUS. “The less European a person is, the less scientists and geneticists know about their diseases.”
One example is an international study in which Colli participated. This study mapped areas of the genome linked to kidney cancer susceptibility and was published in the journal Nature Genetics in 2024. “In previous phases of the study, Brazilian samples were not included out of fear that
racial diversity would reduce the effectiveness of the association analysis,” says the doctor. However, the opposite turned out to be true: when a Brazilian cohort was included in the analyses, a previously unknown genetic variant was found that was present in people of African descent.
When American geneticist Francis Collins, then director of the US National Institutes of Health (NIH), gave a lecture at FAPESP in 2014, geneticist Iscia Lopes-Cendes of the University of Campinas (UNICAMP) asked him about the idea of carrying out a population-wide genome project in Brazil. His response was that it was unnecessary since human genetic diversity was already well described. “He was completely wrong. North Americans don’t understand that other Latin populations are not the same as Mexicans,” she laughs, not convinced by the answer. In 2015, Lopes-Cendes founded the Brazilian Initiative on Precision Medicine (BIPMed). “It is the first genome database in Latin America,” she says.
“We have a partnership with the Genomas Angola (GENAN) project, and we have already collected 750 samples,” adds the researcher, who

is supervising an Angolan doctoral student on the project. Lopes-Cendes hopes to find genetic variants that have not yet been described and that could have practical uses in both countries, which have ancestral links as a result of slaves brought over during the colonial period.
“If there is a place where precision health care can be made available to everyone, it is in Brazil,” she says. “We have SUS.” She refutes the notion that the technology would be available only to rich countries and people. On the contrary, she believes that it can be an important tool for preventive medicine. “Personalized health care allows for more efficient treatments, at the right dosages, for the right people, with fewer side effects and lower costs.”
Together with geneticist Thais de Oliveira, a postdoctoral researcher at her lab, she published an opinion piece in the journal Annual Reviews of Genomics and Human Genetics in January, emphasizing the importance of public databases of genome information about Latin American populations. Argentine geneticist Rolando González-José of the Patagonian National Center (CENPAT), head of the Argentine Population Genome Reference and Biobank Program (POBLAR), agrees. “It is important for governments to make agreements on connecting genome databases in the region,” he suggested in an email to Pesquisa FAPESP. Like Colli, he says that short-read sequencing has benefits in regard to optimizing available budgets.
The DNA do Brasil project, which is part of the Genomas Brasil Program, aims to contribute to precision health by providing a detailed overview of Brazilian genetic variation. The pharmaceutical industry could also benefit from these advances. In 2021, USP geneticist Lygia da Veiga Pereira, the founder of the project, used the knowledge that she acquired throughout her academic career to create a startup called gen-t, now funded by FAPESP's Innovative Research in Small Businesses program (PIPE). “We are building a health, lifestyle, and multiomics data infrastructure with 200,000 genomes, which can be used by the industry to accelerate the search for new drugs,” she explains.
The initiative could complement potential implementations of new strategies by SUS. “We are just at the beginning of understanding the impact of genomics on population health,” says Colli. l
Interview Luiz Henrique Lopes dos Santos
The call of logic
A philosopher revisits his academic journey and reflects on more than 30 years working with research funding management at FAPESP
ANA PAULA ORLANDI E FABRÍCIO MARQUES portrait by LÉO RAMOS CHAVES
In 1972, at just 22 years of age, Luiz Henrique Lopes dos Santos became a faculty member in the Philosophy Department at the School of Philosophy, Languages and Literature, and Human Sciences at the University of São Paulo (FFLCH-USP), where he had earned his bachelor’s degree and is now a senior professor. At the time, he was part of a group of young researchers invited to fill the gap left by the compulsory and early retirement of professors persecuted by the military regime. Under the guidance of big names such as Otília Arantes, José Arthur Giannotti (1930–2021), and Oswaldo Porchat (1933–2017), Santos forged a career that spanned the philosophy of logic and history of philosophy, and he worked at institutions such as USP, the University of Campinas (UNICAMP), École Normale Supérieure in Paris, Paris Diderot University, and the Federal University of Rio de Janeiro (UFRJ). His academic production involved mainly the works of German mathematician, logician, and philosopher Gottlob Frege (1848–1925), the topic of his PhD thesis defended in 1989 at USP, and of Austrian philosopher Ludwig Wittgenstein (1889–1951). One of his most notable contributions was the translation into Portuguese, accompanied by a critical introduction, of Tractatus logico-philosophicus, written in 1921 by Wittgenstein. In addition to his teaching and academic work in philosophy, he was involved in the management of research funding. For more than three decades, he was the philosophy and humanities coordinator of FAPESP's Scientific Board where he assessed thousands of projects proposed by researchers and helped formulate programs for the Foundation. His work at FAPESP included the scientific coordination of Pesquisa FAPESP magazine for 21 years and the formulation of the Foundation’s Code of Good Practices in 2011. On a summer afternoon in February 2025, he granted the following interview. Shortly afterward, Lopes dos Santos was diagnosed with cancer and passed away in July.
Where did your interest in philosophy come from?
When I joined the high school movement, at approximately 15 years old, I began reading political philosophy and soon moved on to philosophy in general. However, when it was time to choose which career to pursue, I was undecided between the more classic route of law, in my case, and philosophy. I come from a family with many lawyers, and my father, who was a stockbroker, wanted me to study law. I took the university entrance exam for both courses, and in 1968, I began law at USP in the morning and philosophy at PUC-SP (Pontifical Catholic University of São Paulo) in the afternoon.
When did you decide your professional path?
In the 1960s, for an academic career, the natural path for a philosopher was minimally institutionalized. This caused a certain degree of insecurity. The person who put me on the philosophy path was Otília Arantes, who was my professor at PUC and one of my main academic

FIELD OF EXPERTISE
Philosophy of logic and history of philosophy
INSTITUTION
School of Philosophy, Languages and Literature, and Human Sciences at the University of São Paulo (FFLCH-USP)
EDUCATION
Bachelor’s degree (1971) and PhD (1981) from USP
references. She showed me that such a professional path was possible. When I decided to transfer my philosophy course to USP, mainly because of Otília’s influence, I already felt that the balance was tipping toward philosophy. I took the entrance exam again and enrolled in the class of 1969.
How was the transition to studying philosophy at USP?
It was a little frustrating. At the time, the department had lost professors who had been persecuted by the military regime. In my first month, I had a class with José Arthur Giannotti, who was soon forced into early retirement, just like Bento Prado Júnior (1937–2007). Others had to flee Brazil, such as Ruy Fausto (1935–2020). The department was left completely understaffed. In mid-1969, I went ahead and bravely scheduled an interview with Giannotti at CEBRAP (Brazilian Center of Analysis and Planning), which he helped to fund. I said, “I came to study philosophy at USP because of professors like yourself, who are no longer here. What do I do? Giannotti was preparing an article about Durkheim (1858–1917), who is a sociology theorist, and asked me to read some texts and make a presentation for him. I passed the test, and from then on, I informally began what is now called scientific initiation under Giannotti’s guidance. Every 15 days, I would go to his house to talk about Kant. We became good friends.
Did you graduate in law and philosophy?
For three years, I took both courses simultaneously. It continued like this until Oswaldo Porchat’s assistant, who was my logic professor, accepted a great job offer in financial terms at Banco do Brasil. At the end of 1970, Porchat came looking for me and said that if I finished the course the following year, I could be hired as his assistant. To be able to complete two years in one, I had to give up law, but I left it knowing that I was beginning a career in philosophy. The call from Porchat was decisive because I was undecided between aesthetics and logic.
What was it like becoming a university professor at such a young age?
Of course, I was very nervous. I was 22 years old, younger than most of the stu-
dents. But, as I said, the department was really understaffed. I remember that other professors my age were hired such as Carlos Alberto de Moura, Ricardo Ribeiro Terra, and Olgária Mattos. Some of them were invited by Giannotti to take part in a seminar at CEBRAP, which ran between 1971 and 1973. This experience was truly important for my training because of the high level of the debates.
Did the news of the job leave your father more relaxed regarding your career choice?
He was relieved when he heard the news because he was extremely concerned about my future. Unfortunately, he died soon after, at age 49, at the end of 1971. He was a well-off man, but he was never rich. He preferred traveling to saving money. With his death, my mother, who was a housewife, had to support herself. She went to work with her brother and decided to study social sciences. At around 43 years of age, she passed the entrance exam at USP in the 1970s. We used to cross paths at university, me as a professor and she as a student. After graduating, she went to work at the Support Foundation for Imprisoned Work-
ers, where she remained until she retired in the 1990s. Her role was taking care of the literacy part, and in this job, she had contact with inmates such as Chico Picadinho, the famous serial killer from the 1960s and 1970s. My mother was very dynamic and even back when she was a housewife, she participated in progressive Catholic activism. In fact, her actions even influenced me to join the high school movement in 1964, just before the military coup.
What did you study for your master's degree?
I do not have a master’s degree. I started doing the research for my master’s degree in 1972 at USP on mathematics, logic, and the German philosopher Gottlob Frege under Porchat’s guidance. However, when I was about to start writing the dissertation, Porchat called me to be his righthand man not only at the Center of Logic, Epistemology, and History of Science but also at the Department of Philosophy that he was going to set up at UNICAMP. This was in 1975. On accepting the invitation, he warned me that it would be unfeasible to continue the research for my master’s degree at that time.
How did the idea of the center come about?
When my father died, my mother had to go to work, and at the same time, at around age 43, she enrolled in the social sciences course at USP
Porchat had the idea to create it at USP, but the department of philosophy rejected the proposal because of ideological differences. We were living in a highly polarized environment. Those of us in the field of logic were considered reactionary and were alienated because some people from the department believed that the discipline was linked to capitalism. However, Porchat was a good friend of the then-vice dean of UNICAMP, engineer and physicist Rogério Cesar de Cerqueira Leite (1931–2024). He told the dean of UNICAMP at the time, Zeferino Vaz (1908–1981), that it was a golden opportunity for the university in the field of philosophy. Zeferino fell in love with the idea of an interdisciplinary center and provided the material resources that no initiative linked to philosophy had in Brazil at the time. This made it possible, for example, to bring in visiting researchers from abroad and organize international conferences. The center was founded in 1977 and remains active.
What was its composition?
It was composed of researchers from the Department of Philosophy at UNICAMP and from areas such as mathematics, sociology, physics, linguistics, and theology. I was assigned to make the link to the Institute of Language, where I gave classes between 1977 and 1981.
Was there a community of logicians in Brazil?
There was, but it was, and still is, very small. The most well-known was Newton da Costa (1929–2024), who was at USP at the time but was a major influence on some members of the center, such as Ayda Arruda and Itala D’Ottaviano. At that time, I also became closer to Newton and his paraconsistent logic, after having published a few papers. Beyond its contributions to the realm of logic, the center was fundamental in shaping an academic philosophy community in Brazil. At the time, several centers had very qualified people spread across various states in Brazil. By connecting these islands of knowledge through its activities, the center contributed, for example, to the creation of ANPOF (the National Association of Graduate Studies in Philosophy) in 1983.
What did you study in the PhD program?
My PhD, supervised by Porchat, was an extension of that unfinished research from my master’s degree. I sought to understand how Frege, in the second half of the nineteenth century, caused a break from the Aristotelian model of logic, which had prevailed for approximately 2,000 years. To answer the questions that arose during his research into the fundamentals of mathematics, he was obliged to rethink logic. Thus, he conceived what we today call mathematical logic. I was hired by UNICAMP as a professor with a PhD on the condition of finishing my thesis in 1980, but it was a battle to complete the research. Between 1975 and 1978, I barely touched my thesis because I was immersed in the bureaucracy of the department and center, teaching classes, and holding seminars. In 1978, I returned to my thesis and defended it in 1981. The work was published in 2008 as O olho e o microscópio (The eye and the microscope; Nau Editora]).
The center that we created at UNICAMP in the 1970s was fundamental in shaping the academic philosophy community in Brazil
that I wrote to explain the place of the Tractatus in the history of philosophy is longer than the book itself. Giannotti had already translated this work and written an introduction to it back in 1968. It was the second translation in the world, after the English one, and it was a Herculean task on Giannotti’s part, considering that Wittgenstein had only been dead for 17 years. He was a contemporary, and there was practically no literature on his work. In the 1990s, EDUSP proposed that Giannotti produce a new edition of his Portuguese version.
Giannotti himself said that the work that he did in the 1960s contained many errors. Do you agree?
You stayed at UNICAMP until 1981. Why did you decide to go back to USP? I returned for personal reasons. I had separated from my wife, and my children, who were still small, lived with their mother in São Paulo. Since I did not want to be on the road all the time, I returned to the department of philosophy at USP. At that time, Giannotti had also returned to USP, and together, we taught Introduction to Philosophy to first-year undergraduates. He gave what he called an introductory lecture, and I held seminars with the students while dissecting the texts, reading, and rereading them several times. We educated several generations of philosophers.
In the 1990s, you translated Tractatus Logico-Philosophicus for EDUSP, a book written in 1921 by Austrian philosopher Ludwig Wittgenstein. What were the challenges of this work?
It is not easy translating such complex writing as that of Wittgenstein, who is one of the great philosophers of language, from German to Portuguese. To give you an idea, the introductory study
There were some errors, not so much in the translation from German, but conceptual errors, because there was very little familiarity with the field at the time. This is the case with the specific German philosophy terms from the nineteenth century that related to philosophers such as Franz Brentano (1838–1917), who few people had read in Brazil. Upon receiving an invitation from EDUSP in the 1990s, Giannotti asked me to review the work, but I felt that it would become Frankenstein’s monster and proposed redoing the translation. Giannotti agreed and handed the mission over to me.
Between 1986 and 2007, Giannotti was in charge of CEBRAP’s Professional Training Program. What was your role in it?
This was an interdisciplinary training program aimed at postgraduate students from different fields of knowledge, which was made possible by an agreement between CAPES (the Brazilian Federal Agency for Support and Evaluation of Graduate Education) and CEBRAP. It was difficult to enter. Over the course of two years, students participated in activities such as seminars on anthropology, political science, sociology, economics, and philosophy. The meetings were held twice a week, and the teaching staff included Paul Singer (1932–2018) and Ruth Cardoso (1930–2008). I actively participated in the philosophy center until going to Paris in the late 1990s.
You joined FAPESP in 1986. What was the Foundation like at that time?
In 1986, Flavio Fava de Moraes, who was the scientific director at FAPESP, invited me to substitute for João Paulo Monteiro (1938–2016) in the field of philosophy on the Board of Human and Social Sciences. There was no general coordinator, but the role, because of his personality and background, was filled by Leôncio Martins Rodrigues (1934–2021). There was Boris Fausto (1930–2023) in history, Maria Alice Vanzolini in psychology, Cláudia Lemos in linguistics, and me in philosophy.
The workload at the time was small compared to what it is today, right? We would go in on Mondays, and in the first part of the meeting, we would discuss Sunday’s soccer results—Boris, like me, was a die-hard Corinthians fan. We had approximately 15 or 20 proposals to analyze each week. Each of us would get around four. We studied them, produced a report, and decided whether to approve the grant or funding. Then, we went home. It was another world. A change had just taken place that would transform the profile of FAPESP in the shape of an amendment to the State Constitution proposed by congressman Fernando Leça and approved in 1983. It determined that allocations from the Treasury to FAPESP, then fixed at 0.5% of tax revenue, be calculated based on the current year and allocated in twelve monthly installments. Previously, the calculation was made on the basis of the previous year’s revenue, and by the time that the funds arrived, they were eroded by 13 months of inflation. After the Leça Amendment, the Foundation became aware that it had financial power to reach much further. This was completed in 1989, when the new State Constitution increased funding for the Foundation to 1% of the state’s tax revenue.
In practice, how did this ambition materialize?
One of the milestones was the thematic projects initiative. FAPESP had had large projects in the 1960s and 1970s, but they were one-offs, such as the biodiversity survey of the Amazon performed by zoologist Paulo Vanzolini (1924–2013) in the 1960s. Thematic projects were the first regular line of major funding. A discussion arose within FAPESP about whether
it was worth giving so much money to the humanities—it was one thing awarding grants for master’s degrees, but approving the budget for a thematic project was something very different. The credit goes to Fava, who really put his foot down. One of the first thematic projects in humanities was by filmmaker Jean-Claude Bernardet, from USP, whose product was a film. I remained a philosophy coordinator until 1989. Leôncio left, and Fava invited me to take over as adjunct coordinator. Until 1989, area coordinators would go to FAPESP once a week and did not have any organic relationship with the Foundation. With the creation of the adjunct coordinator role by Fava, the adjunct coordinator began to mediate between the area coordinators and the scientific director. In 1993, José Fernando Perez took over the Scientific Board, he asked me to continue, and I accepted.
In 1997, you stepped away from FAPESP to spend a period in France but returned to the Foundation upon returning to Brazil. How was that return?
I spent two years in Paris as a visiting researcher at the École Normale Supérieure
and as a professor at Paris Diderot University. Paula Montero replaced me. When I returned, in early 1999, I was called to work with Paula because there was already the need for two adjunct coordinators in the humanities. Perez had his own creative dynamic and restructured the Scientific Board. He increased the number of adjunct coordinators, and every week, we met for two or three hours in a discussion circle to discuss what was happening. Many FAPESP programs were born from these meetings. The vibrancy of Perez’s tenure came from having people from all areas talking to one another. This was taken to an even larger scale when Carlos Henrique de Brito Cruz took control of the Scientific Board in 2005. Everything went through the adjunct coordinators. Once a month, 15 adjunct coordinators met and spent the entire afternoon talking.
How many scientific directors have you worked with?
One of the first thematic projects in humanities was by filmmaker Jean-Claude Bernardet from USP, whose product was a film
There were four. The last tenure, of Luiz Eugênio Mello, was heavily disrupted by the pandemic. He worked miracles. He replaced me as an adjunct coordinator with Ângela Alonso, but I got to know her personally only at the end of his term. He kept the Scientific Board working and accomplished important things such as the effort to create research on COVID-19 and the first projects from the Generation Program, which was aimed at younger researchers still without employment relationships. He also promoted the adoption of equality and inclusion policies. Fava’s administration gave FAPESP greater ambition and created an institutional structure so that the Foundation could work creatively. Perez took advantage of this and was assisted by his personality. He was the embodiment of enthusiasm. When Brito took over, many programs were already in their fourth or fifth year. Brito, also because of his personality of being rational and systematic, brought order, formalized things, and assessed what was working and what was not. He improved and refined the existing programs and began a strong push to internationalize research in São Paulo.
What was your contribution to implementing the Public Education Program?
One of the revolutions that Perez implemented was creating technological research programs, especially in partnership with companies. However, he had the wisdom to consider a broad view of applied research. Research in the humanities can be applied and result in the formulation and implementation of public policies. Perez believed that applied research requires a partner who will potentially use it. From there, the idea emerged of starting with public education and conducting research in partnership with public schools. We called Maria Malta Campos from PUC-SP and the Carlos Chagas Foundation to assist us. I coordinated for a period and passed the baton to Marilia Sposito. Because it was successful, there was demand and partnership; it had everything, and then, the Public Policy Program was launched.
How did Pesquisa FAPESP magazine come about, of which you were the scientific coordinator between 2001 and 2022?
The concept was born out of a conversation between then-Editor-in-Chief Mariluce Moura and Perez. I came on board when it was already in motion because I was in Paris when the idea first came up. From the beginning, the goal was to create a magazine, not for FAPESP, but for scientific communication in Brazil and especially São Paulo. Second, it had to be a journalistic outlet and guided by scientists. For this, it was fundamental for the magazine to be a project linked to the Scientific Board. This enabled the creation of standards that guaranteed the quality that the magazine developed.
Do you mean, for example, that the magazine has a Scientific Committee composed of area coordinators and adjunct coordinators from the Scientific Board?
From the outset, the articles in the magazine were read by the coordinators of their respective areas. The idea was to have a balance between journalistic language and scientific rigor. On the one hand, some people said that the magazine was not rigorous enough from a scientific point of view. On the other hand, it presented things that were difficult for the lay public to understand. Criticism from both sides indicated to us that the
The good practices policy should be pedagogical, but one way of educating is by not allowing the wrong things that happen to go unpunished
which resulted in a text in early 2011 that today is on the FAPESP website. Then, Brito asked me to write a preliminary draft of a Code of Good Practices. For six months, I dedicated myself to this task. I discussed the preliminary draft with Celso Lafer, then the president of FAPESP, who gave it the necessary legal backing. The second version was completed, which Brito circulated among the associate deans and scientific societies. We conducted a wide-scale consultation and published it at the end of 2011. Ten years after the code, all of the public universities in São Paulo have a good practices commission.
Afterward, you began overseeing the cases of misconduct that reached the Foundation.
magazine was on the right path by taking the middle road.
In 2001, you and Professor Perez wrote an article about conflicts of interest in research. Was this the beginning of the debate that would lead to the Code of Good Practices a decade later?
It was a localized issue. FAPESP did not have a conflict of interest policy because there had never been a serious problem related to it. There was a serious problem with a research project that assessed the health risks of asbestos. A large amount of money was invested, and the results were favorable to asbestos. It was subsequently discovered that the researcher had a relationship with a company that produced asbestos.
How did the Code of Good Practices come about?
It just came out of the blue for me. In September 2010, I had undergone appendix surgery in Rio, and while recovering, I received a request from Brito to study what existed in the world regarding good practices. I performed this study,
I always insisted, and Brito strongly supported this, that the main axis of the good practices policy must be pedagogical. However, one way of educating is by not allowing the wrong things that happen to go unpunished. It is necessary to have a rigorous and fair system for receiving complaints, investigating, and ensuring the transparency of the results. This requires a lot of work. When you receive a complaint, you have to guarantee time for a defense. It is the institutions that are equipped to investigate what happens on their premises. They can do so impartially and objectively, but there are situations in which they can be swayed by corporatism. In such cases, it is necessary to reject the institution’s investigation, which results in a political crisis. I took care of this from 2011 until 2023. The majority of the cases did not cause confusion, but the few that did were difficult.
Do you divide your time between São Paulo and Rio de Janeiro currently?
Yes. I am a senior professor at USP and supervise postgraduate studies in philosophy. Additionally, I am a collaborating professor at UFRJ, where I participate in seminars and teach short courses. As I am retired, I now have more time to dedicate to academic writing. In the past five years, I have been delving into Aristotle’s way of thinking and have already published some articles on the topic. But I am in no rush. Theoretical production in philosophy is a task that requires patience. l
Linking universities and businesses

Survey maps activities at 240 academic laboratories to understand how they interact with the industrial sector
FABRÍCIO MARQUES
How do universities and companies in Brazil work together to generate knowledge? Two researchers from the School of Economics, Business, and Accounting of the University of Sao Paulo at Ribeirão Preto (FEARP-USP) attempted to answer this question by examining which factors were associated with interaction between companies and 240 public university laboratories in São Paulo State. Some of the study’s conclusions, published in December 2024 in the journal Science and Public Policy, confirmed the results of similar studies conducted in other countries: Compared with laboratories that are less involved with companies, those that have more engagement stand out for their skills in prospecting and attracting private initiative partners, have access to advanced equipment, and

have more permanent researchers to support joint projects. They also receive more support from their departments to facilitate cooperation.
However, there are peculiarities in Brazil, one of which is that the senior level of faculty staff does not interact significantly with industry, an aspect that is more readily observed in the US and Europe with the gradual formation of collaboration networks over professors’ careers. Among the 240 São Paulo State laboratories analyzed, only 55 were led by tenured professors, the highest level in the public academic career, while 114 were led by lecturers or associate professors, and 71 were led by fellow professors. According to the research coordinator, FEA-RP-USP researcher Alexandre Dias, this outcome highlights the marked differences between the science, technology, and innovation (STI) systems in Brazil and those in more developed countries.
“In public Brazilian universities, research and extension are indivisible, and academics at their highest career level usually get closely involved in the management of their units. The predominance of public research funding, the rewards system, and the criteria by which faculty staff are assessed for career progression do not contribute to individual performance aligned with interaction with the industrial sector,” says the researcher, who conducted the survey with Leticia Ayumi Kubo Dantas; he advised on her master’s dissertation, defended in 2023. The two are part of the Center for Research in Innovation, Technological Management, and Competitiveness at FEA-RP-USP.
The key objective of the study was to analyze the degree of “academic engagement” among research laboratories in Brazil. This concept, proposed in 2013 by Markus Perkmann of the UK’s Imperial College London Business School, brings together a set of formal and informal activities that modulate the interaction between universities and the business world. “For a long time, researchers have striven to understand what drives the commercialization of technologies and academic entrepreneurship as phenomena to analyze university–corporation interaction. In the last decade alone, interest has also grown in investigating other channels by which links are forged between universities and companies,” Dias explains.
Laboratory data from seven institutions were analyzed—state-level institutions São Paulo State University (UNESP), the University of Campinas (UNICAMP), and the University of São Paulo (USP), as well as the federal universities of São Paulo (UNIFESP), São Carlos (UFSCar), and ABC (UFABC), and the Aeronautics Technology Institute (ITA), whose leaders agreed to complete an online questionnaire. In terms of knowledge areas, 20% of the laboratories worked with assorted engineering disciplines—15.8% health sciences, 14.5% biological sciences, 12.5% exact and earth sciences, and 9.6% agrarian sciences; additionally, 27.5% operated across multiple areas.
The research facilities were separated into three categories: The largest group, with 112 laboratories, presented minimal, sporadic involvement with companies. The second group comprised 84 laboratories and demonstrated partial engagement with private initiatives. The third group, consisting of 44 laboratories, stood out for its interaction with companies through different channels: collaborative research (52.3%), research contracts (40.9%) and the expansion of facilities funded by private sources (34.1%). These laboratories also participated in informal interactions, such as postgraduate student train-
Laboratory for New Materials & Devices at São Paulo State University (UNESP) in Bauru: Partnership with overseas company
ing in industry projects (15.9%) and consultancy services (22.7%).
The economic value of equipment in these highly engaged laboratories, along with the number of permanent researchers, was found to be three times greater than that in laboratories interacting minimally with companies. Support from departments with which the laboratories are associated was more significant among those engaging significantly: 32% stated that they received sufficient support, compared with 13.4% of those having minimal engagement and 22.6% in the intermediate category. According to Leticia Dantas, the lead author of the study, the research demonstrates the importance of enhancing university laboratories and ensuring a robust structure and larger teams. “This not only boosts academic engagement but also makes laboratories more attractive for partnerships with industry, multiplying the impact of research in the productive sector,” she says.
Economist Eduardo da Motta e Albuquerque, of the Federal University of Minas Gerais (UFMG) and a researcher at the university’s Center for Development and Regional Planning (CEDEPLAR), who did not participate in the study, agrees that one of the takeaways of the article lies in demonstrating the importance of enhancing research laboratories in the Brazilian university system. “Interaction attracts funds to laboratories and has an impact on the quality of research, bringing new themes for investigation to the university,” says Albuquerque, a specialist in the formation of innovation networks and the forging of links between universities and companies.
“It would also be interesting to widen the survey and find out which industrial segments interact most with the laboratories,” he says. He would bet that there are noteworthy interactions occurring in the agricultural sector, given its economic importance for Brazil, but very little going on with the large pharmaceutical companies, which base their research at overseas headquarters. Albuquerque sees a warning sign in an outcome presented in the article, according to which no correlation was found between the engagement of laboratories with companies and the support provided by the Technological Innovation Centers—offices created under the 2004 Law of Innovation—at public science and technology institutions to manage intellectual property and lend support to university–industry interaction. “The country invested heavily to set up these centers; maybe it’s time to have another look at their function,” he says.
The relationship between universities and companies needs to overcome a series of obstacles, says chemist Elson Longo, an emeritus professor at the Federal University of São Carlos (UFSCar) and director of the Center for the Development of Functional Materials (CDMF), one of the Research, Innovation, and Dissemination Centers (RIDC) funded by FAPESP. “Some of the interaction comes through consultancy services offered by researchers to companies. There needs to be more ambitious cooperation to obtain new knowledge and develop innovative products,” he says, giving examples of projects set up by the RIDC in recent decades with the steelmaking and ceramics and cladding industries, which brought changed production methods and productivity gains—the institution currently has partnerships for the development of inputs for cosmetics factories. He also draws attention to the low levels of interest among multinationals in collaborating with Brazilian groups, as a rule preferring to use research and development (R&D) structures at their headquarters.
Emilio Carlos Nelli Silva, of the Department for Mechatronics and Mechanics Systems at the Polytechnic School of the University of São Paulo (USP), sees marked differences between interaction among universities and companies in Brazil and this type of interaction in other countries. “The relationship is more fluid in the United States because companies hire PhDs to work in their R&D centers, and liaising with university groups is done through them. Here in Brazil, as there are still very few PhDs in companies, other actors are involved, and sometimes, there is a lack of understanding that research can come up against obstacles,” he adds.
Funding is another difference. “It’s not our culture here to invest risk capital in promising

Engaged laboratories interact with companies through multiple channels

research, although in certain areas like petroleum and electricity, companies have a legal obligation to invest in R&D, and this creates good opportunities for research partnerships,” he says. Silva is the vice director of the engineering program at the Greenhouse Gases Innovation Research Center (RCGI), one of the Applied Research Centers/Engineering Research Centers funded by FAPESP in partnership with companies—in this case, Shell. The program offers nonreimbursable funds for corporate projects, requires the counterpart funding to be equal to or to exceed the public investment, and engages university research groups of excellence. “The centers create new paradigms for collaboration between universities and companies and bring clear benefits for society.”
According to physicist Carlos Frederico de Oliveira Graeff, of the School of Sciences at UNESP’s Bauru campus, liaising between universities and industry has improved, but there are still things to work out. “Industry doesn’t always get solutions for its problems from academia, just like researchers who make efforts to interact don’t necessarily find companies interested in their expertise,” he says. Graeff runs the Laboratory for New Materials and Devices, which is one of the research facilities participating in the FEA-RP-USP study and is classified among the laboratories with high levels of engagement. The facility, which is currently seeking new materials for use in electronic devices such as solar cells and transistors, is cooperating with two companies: One is a Singapore-based startup seeking uses for the discarded waste of industries that use flies as raw material to produce
animal protein. The challenge is to make use of large volumes of discarded fly exoskeletons (outer shells), which are rich in the biomolecule melanin. Graeff’s group is looking at possible applications for the compound in batteries and capacitors because of its potential for storing energy. The other is a Brazilian company, to which the laboratory transferred useful technology for the production of perovskite solar cells, developed as part of a project supported by Petrobras.
Graeff believes that interactions could be more gainful if Brazil had wider access to multiuser platforms and analytical centers that company researchers could call upon. “Startups need cutting-edge equipment to develop products, and they don’t often have the funds to acquire it,” says Graeff, the former coordinator of Strategic and Infrastructure Programs at the FAPESP Scientific Department. The physicist also considers it pertinent to expand operations at research institutions working with applications at an intermediate level of technological maturity, which still require effort and investments to take a product to market. “The Brazilian Agricultural Research Corporation (EMBRAPA) performs this function in agribusiness, and the National Service for Industrial Training (SENAI) has reached out to many different industrial segments through its Innovation Institutes,” he says. Graeff also highlights the model used by the FAPESP Science Centers for Development (CCD), which bring together researchers from state-level institutes, universities, companies, and government bodies in the quest for solutions to issues in society, from agricultural output to urban mobility. “These centers are mobilizing the system around mission-oriented research,” he concludes. l
Laboratory for Fuel Cells and Reactive Conversion at POLI-USP: Innovation and greenhouse gases
Good ball skills and reasoning

The volley by striker Richarlison that sealed the win over Serbia at the 2022 World Cup
Players from elite Brazilian soccer teams present better memory, planning ability, and mental versatility than nonathletes of the same age do
GISELLE
SOARES
On Thursday, November 24, 2022, Brazilians watched attentively as the national team played its opening match against Serbia at the World Cup in Qatar. More than two years later, perhaps few remember the game, which ended with a 2–0 victory for Brazil, but the striker Richarlison’s volleyed goal remains etched in the memories of soccer fans. With his left foot, he cushioned the ball crossed with the outside of the boot by Vinicius Junior and, in a choreographed leap, struck a precise shot with his right foot past the opponent’s goalkeeper. Chosen as the goal of the tournament in a public poll by the International Federation of Association Football (FIFA), the moment illustrates the athlete’s profile on one of his social media accounts.
Moments such as these, which captivate even those who do not follow the sport, do not rely exclusively on luck or extraordinary physical ability. In addition to a deep technical understanding of the game, athletes who pull off such moves demonstrate superior abilities in processing information and making decisions than individuals of the same age and educational level do, according to a study published in January in the scientific journal Proceedings of the National Academy of Sciences (PNAS)
In this study, an international group of researchers that included Brazilian Alberto Filgueiras, of Central Queensland University in Australia, investigated the personality traits and cognitive abilities of 153 players from teams in Brazil’s top league, Série A, and 51 players from the top division of Sweden’s national league—the athletes ranged from 17 to 35 years of age. According to the authors, this is the most extensive psychological and cognitive assessment conducted on the largest number of elite players to date.
Previous studies included few athletes at the peak of their careers and only some of the tests.
In the study published in PNAS , each player underwent three sets of neuropsychological tests. The first defined the personality traits of the participants. The other two tests, one of which was developed by Filgueiras and colleagues and published in 2023 in the journal BMC Psychology, measured their cognitive abilities—characteristics such as creativity, mental flexibility, and shortterm memory—as well as the ability to sustain attention, plan and solve problems, and inhibit inappropriate responses.
For all the cognitive tests, the soccer players achieved higher average scores than the reference values for individuals of the same age group or for members of the control group, which was composed of 124 Brazilians from the same age range and educational level who did not play soccer.
The superiority of the soccer players in terms of these cognitive characteristics, important for quick reactions, changing strategies, or creating chances in the heat of the game, was complemented by personality traits that also favored self-confidence and teamwork. Compared with the participants in the control group, the athletes presented higher levels of extraversion, openness to new experiences, and conscientiousness (a trait linked to ambition, self-discipline, focus, and self-control). In turn, the control group scored higher than the athletes in characteristics such as agreeableness and neuroticism, with the latter referring to the tendency to experience negative emotions, such as anxiety, anger, frustration, and guilt.
These results, according to the researchers, suggest that elite soccer players tend to be more sociable, disciplined, and adaptable than individuals in the control group are. In contrast, compared with soccer players, nonathletes demonstrated greater emotional instability and
a greater tendency to follow social norms without questioning them.
As a continuation of the study, the authors used the personality traits and cognitive performance of all the participants to teach two artificial intelligence programs to distinguish elite soccer players from nonathletes. They also used one of these programs to identify which personality traits and cognitive abilities contributed most to recognizing who was a top-level soccer player. Afterward, exclusively based on the personality data and cognitive test results, they asked the program to select who were the elite athletes— the algorithm chose correctly 97% of the time.
For the final stage of the research, to verify whether these characteristics could predict the players’ on-field performance, the researchers compared the psychological profiles and the cognitive abilities of the Brazilian athletes with their actual performances (goals, shots on goal, passes, and dribbles) during the 2021 season of the Brazilian Championship, the Copa Sudamericana, and the Copa Libertadores da América—the Swedish players were excluded from this phase because of a lack of data. The players who scored higher on the scales of conscientiousness and openness to new experiences scored more goals, whereas those with better memory successfully completed more dribbles.
“Our results show that cognitive abilities, such as planning and mental flexibility, are directly linked to performance in soccer, influencing metrics like goals, dribbles, and assists,” said Italian psychologist and neuroscientist Leonardo Bonetti, a professor at Aarhus University in Denmark, a researcher at the University of Oxford in the UK, and lead author of the study in PNAS, to Pesquisa FAPESP. A graduate in classical guitar and psychology with a PhD in neurosciences, Bonetti studies the brain mechanisms behind memory and cognitive abilities.
“Our article aims to identify a typical cognitive and personality profile of elite athletes,” explains Filgueiras, coauthor of the study. “Until now, we have known that elite athletes have better physical abilities and technical-tactical knowledge than the rest of the population, but we were always met with the stereotype of the unintelligent athlete, who only has physical skills,” he says. The researchers have shown that their mental characteristics, particularly personality and executive functions, differ from those of the general population. “It would be a sort of sports intelligence, focused on solving problems and making effective decisions on the soccer field.”
One finding that attracted the attention of researchers was the low level of agreeableness among elite athletes; in other words, a tendency to question direct orders. “This makes us reflect on the role of the coaches, who often give a lot of instructions and commands. Interestingly, these athletes do not obey them automatically. They question them and need to be convinced that the instructions make sense before following them,” says Filgueiras. “This is not about impulsiveness but rather about autonomy and confidence in their own decisions. If a coach says, ‘Do it this way,’ the response will likely be ‘Why? The other way seems better,” the Brazilian psychologist adds.
This trait, according to the researchers, could be linked to what is commonly known as “game intelligence,” a skill that involves not only awareness of the environment but also the ability to adapt to sudden changes and maintain stable performance. Ricardo Picoli, psychologist at Esporte Clube Bahia and coordinator of the Specialization Program in Exercise and Sport Psychology at the Federal University of São Carlos (UFSCar), states that this ability is particularly relevant in practical situations, such as changes in formation or shifts in game scenarios. “Players with this more developed capacity are able to better assess long-term career opportunities, avoiding choices that may seem attractive initially but could be harmful in the future,” adds Picoli, who did not participate in the study.
The authors of the study from PNAS argue that the results could be used by clubs and coaching staff to improve training methods by incorporating cognitive and psychological testing into player evaluation and development. “Analyzing these skills allows for a more precise approach
A dispute for the ball between Felipe Luis, of Flamengo, and Carlos Palacios, of Internacional, in a Série A match during the 2021 Brazilian Championship


to be taken in selecting athletes, defining roles within the team, and refining training strategies,” affirms Bonetti. “Success in soccer depends not only on physical attributes but also on psychological traits and cognitive abilities, which play an essential role in the performance of high-level players.”
Using psychological assessments to try and understand and improve athletes’ performance is not new. In recent decades, sports psychology has sought to map how psychological factors influence a player’s performance and how they can be applied to enhance training, explains sports psychologist Kátia Rubio, a senior associate professor at the School of Physical Education and Sport of the University of São Paulo (EEFE-USP) and coordinator of the Olympics Study Group (GEO-USP), in an earlier study published in 2007 in Revista Brasileira de Psicologia do Esporte
In high-performance sports, these factors were identified through psychodiagnosis, which assesses the athletes’ personality traits and emotional state during training and competition to identify intervention strategies that alleviate symptoms of suffering and improve emotional well-being. “With the result of the diagnosis, conclusions can be made about individual or group characteristics that support the selection of new athletes for a team, adjusting training, individualizing technical-tactical preparation, choosing the strategy and
tactics to use in a competition, and optimizing psychological states,” writes the researcher in the article from 2007.
In an interview with Pesquisa FAPESP, Rubio, who did not participate in the study led by Bonetti, says that the search for psychological profiles in sports began between the 1960s and 1970s, when psychology tried to establish itself as a science through psychometrics. “In the context of the Cold War, sports were seen as a way of demonstrating power, and there was a lot of interest in making it more predictable, including trying to identify profiles of elite athletes,” recalls the researcher. “However, more than five decades later, there is still not a definitive model that can predict, categorically, who will be a champion. Sporting performance is multifactorial, influenced by psychological, environmental, and social aspects,” he ponders.
This, therefore, is a gap that the authors of the study from PNAS intend to fill by expanding the research to sports teams’ youth academies. Under the coordination of Filgueiras, they plan to research how cognitive traits develop and whether it is possible to predict which players have a greater chance of reaching the elite level. “We’re also seeking to explore the relationship between cognitive abilities, positions on the field, and team balance, since a team doesn’t need players with only one type of cognitive profile to be successful,” says Bonetti. l
The scientific articles consulted for this report are listed in the online version.
Coach Janne Andersson (in white) instructs players from the Swedish national team during a training session held in Spain in 2021

Challenging beliefs
Blood vessels, not just nerves, release compounds that modulate heart rate and blood pressure
RICARDO ZORZETTO
“W
e are flipping the script.” With this bold and confident statement, physician and pharmacologist Gilberto De Nucci concluded lunch at an Italian restaurant in São Paulo last October. The conversation had been rich with new insights into the biochemistry and physiology of the heart and blood vessels—ideas that required time to fully digest. For more than an hour, De Nucci had outlined the findings of his research group at the University of Campinas (UNICAMP), which aims to transform the understanding of how the body regulates heartbeat, blood pressure, penile erection, and ejaculation.
Detailed in over 30 scientific articles published since 2020, the most recent appearing in Life Sciences in February, his team’s findings suggest that the inner lining of blood vessels and heart chambers is the primary production site for a family of compounds that control everything from vascular contraction to the rhythm and strength of the heartbeat. Until now, cardiologists and physiologists believed that the synthesis and release of these compounds, known as catecholamines, occurred exclusively within specific nerve cells.
It was partly by chance that the UNICAMP group began uncovering findings that now challenge this foundational principle of cardiovascular physiology. In mid-2010, during a conversation with a zoologist in Rio de Janeiro, De Nucci was surprised to learn that reptiles were the first animals to evolve penises and that copulation in the South American rattlesnake (Crotalus durissus terrificus) could last up to 28 hours. Years earlier, De Nucci had developed lodenafil, a compound for the pharmaceutical company Cristália, based in the interior of São Paulo, to treat erectile dysfunction. Marketed under the name Helleva, it functions similarly to sildenafil (Viagra). Intrigued by the biology of these snakes, De Nucci investigated the mechanisms behind such prolonged erections.
A plate from the book Tabulae Anatomicae, published in 1552 by Italian anatomist Bartolomeo Eustachio (c. 1500–1574), depicts the heart and the great vessels of the human body
Three of the best-known catecholamines are dopamine, noradrenaline, and adrenaline. Identified between the late nineteenth and mid-twentieth centuries, these are produced in different regions of the brain and central nervous system, where they act as neurotransmitters, transmitting commands from one cell to another. In both real threats, such as an armed robbery, and perceived threats, such as the fear of being mugged, they are synthesized and released by fibers of the sympathetic nervous system, which extend from the thoracic and lumbar spinal cord to various organs and tissues. In such moments, catecholamines, especially noradrenaline, prime the body for fight or flight: they accelerate the heartbeat, trigger the liver to release glucose, constrict blood vessels, and increase blood pressure, mobilizing blood and energy to the muscles.
In humans, erections are affected by emotional factors, neural function, and vascular mechanisms. In response to sexual stimulation, nerves transmitting signals from the brain to the penis stimulate blood vessels to produce nitric oxide (NO). Synthesized by endothelial cells—the inner lining of veins and arteries—NO triggers chemical reactions that cause the vascular smooth muscles to relax. As a result, the penis is filled with blood and becomes erect. After a certain period, the fibers of the sympathetic nervous system release catecholamines—primarily noradrenaline—which induce contraction of the genital tract muscles, leading to ejaculation. Simultaneously, these catecholamines cause the blood vessels in the penis to constrict, resulting in flaccidity.
In an initial study published in 2011 in The Journal of Sexual Medicine , De Nucci reported that the mechanism responsible for erection in the rattlesnake was similar to that in humans and other mammals—dependent on nitric oxide (NO).
The difference emerged in experiments analyzing vascular muscle contraction. In mammals, the loss of erection is triggered by the release of catecholamines from sympathetic nervous system fibers, which cause the muscles to contract and expel blood from the penis. This was not the case in the rattlesnake.
In the snake, the stimulus for vascular muscle contraction—and the resulting penile flaccidity— did not originate from the sympathetic nervous system. Researchers discovered this when they treated tissue with tetrodotoxin, a compound extracted from the puffer fish. In mammals, tetrodotoxin blocks nerve activity, preventing the release of catecholamines and thereby maintaining erection. However, in the rattlesnake, the vessels still contracted and caused erection loss even when nerve signals were blocked, as the group demonstrated in a 2017 article in PLOS ONE. This indicated that the signal for vascular contraction originated from a different source.
Using antibodies, the researchers located, in the endothelium of the rattlesnake’s corpus cavernosum—the cylindrical erectile tissue inside the penis—the enzyme responsible for producing a precursor of dopamine, a catecholamine that also induces muscle contraction. “The ability to contract disappeared when we repeated the experiments after removing the endothelium from the corpus cavernosum,” said De Nucci, who is also a professor at the University of São Paulo (USP), during the 2024 luncheon.
The same effect was observed in tests on the corpus cavernosum and the aorta of the corn

snake (Pantherophis guttatus), the Bothrops snake (Bothrops sp.), and the red-footed tortoise (Chelonoidis carbonaria). The vascular muscles lost their ability to contract when the endothelium was removed and dopamine was eliminated.
At the time, the researchers believed that dopamine synthesis by the endothelium was a unique feature of reptiles. They had searched for the enzyme tyrosine hydroxylase, which produces a dopamine precursor, in the corpus cavernosum of marmosets but did not find it; it was present only in the sympathetic nerves. However, years earlier, researchers in Italy had reported the production of catecholamines by bovine aortic endothelial cells cultured under specific conditions.
This understanding began to shift when pharmacologist José Britto Júnior joined the team. During his PhD interview in 2018, he proposed, “Why not study the vessels of the human umbilical cord? It’s a tissue without innervation and easy to obtain, as it is discarded after childbirth.”
In the initial tests, the researchers found dopamine present in the endothelium of the artery and vein of the umbilical cord. When this endothelial layer was removed, dopamine was no longer detectable. They also observed that the ability of this catecholamine to induce vascular muscle contraction increased when nitric oxide synthesis was blocked, even when the endothelium was intact.
The results, published in Pharmacology Research & Perspectives in 2020, marked a new turning point. During a group meeting, the pharmacologist Edson Antunes from UNICAMP raised an important question: “If the endothelium produces both NO and dopamine, don’t they combine?”
At the time, the answer was unknown, although the possibility existed. More than two decades earlier, a group at the University of Naples Federico II in Italy had combined catecholamines and NO in the laboratory and obtained a derivative compound that was initially believed to be toxic. Concurrently, researchers at Keio University in Japan had identified a form of noradrenaline in rat brains that incorporated NO, known as 6-nitronoradrenaline.
De Nucci began searching for chemical companies capable of synthesizing similar compounds and found one in Canada. He imported samples of 6-nitrodopamine (6-ND)—a combination of dopamine and NO—which Britto and other team members used to calibrate the mass spectrometer, a device that separates and quantifies molecules based on atomic mass, and to test the compounds extracted from the endothelium of umbilical vessels.
Modulated by catecholamines, the contraction of ducts in the genital tract is responsible for triggering ejaculation
Bingo! The presence of 6-nitrodopamine was confirmed, as the group reported in a 2021 article in Life Sciences. Moreover, the concentration of 6-ND decreased when NO synthesis was
inhibited, indicating that NO was involved in its production. The team later determined that this was the principal biochemical pathway, responsible for 60% to 70% of the 6-ND released by the endothelium, although a secondary pathway also exists.
“The idea that catecholamines are also released by the vessels is attractive because the endothelium is in contact with the blood and well positioned to sense metabolic signals and changes in circulatory tension,” said biologist and physiologist Tobias Wang of Aarhus University in Denmark, a recent collaborator with the UNICAMP team, in an interview with Pesquisa FAPESP. “As this proposal is provocative, it is still viewed with skepticism.”
In vessel contraction and relaxation tests, Britto Júnior observed that the effect of 6-ND contrasted sharply with that of dopamine: while dopamine promoted contraction, 6-ND inhibited it. It appears that both compounds compete for binding to the same receptor—D2—which mediates the contractile action of dopamine. When 6-ND binds to this receptor, it blocks the effect.
“It’s also possible that 6-nitrodopamine binds to the same receptor as dopamine, but at a different site, which could explain the potentiation of dopamine’s effects in certain situations,” suggests biomedical scientist and pharmacologist Regina Markus, from USP, who was not involved in the studies.
Following this discovery, the Campinas group began measuring 6-ND levels and characterizing its effects on other vessels and organs of reptiles and mammals. Tests on veins and arteries confirmed the ability of 6-ND to attenuate dopamine-induced contraction. Experiments on anesthetized rats also demonstrated that 6-ND is produced within the heart chambers (atria and ventricles) in greater quantities than classic catecholamines. Furthermore, 6-ND was shown to be between 100 and 10,000 times more potent.
In the atrium, which regulates the rhythm of the heart, 6-ND increases the frequency of contraction. In the ventricle, it enhances the force of blood pumping. Its effect is also significantly longer—up to one hour—than the few minutes typical of drugs currently used in emergencies for cardiac arrest. “6-Nitrodopamine,” says Britto Júnior, “also potentiates the effect of other catecholamines, which could, in principle, allow their use at lower doses than those currently required.”
According to De Nucci, the results demonstrate the capacity of blood vessels and the heart to self-regulate. If confirmed, this mechanism

could help explain why patients who undergo heart and lung transplants—procedures that eliminate the innervation of these organs—are still able to maintain heart rate and blood pressure levels comparable to those of healthy individuals.
“My impression is that the vascular effects of 6-nitrodopamine may influence the self-regulation of blood flow at local and regional levels, acting on capillaries and other vessels without innervation,” says cardiovascular physiologist Ruy Campos Júnior, from the Federal University of São Paulo (UNIFESP), who is investigating the role of hypertension in kidney disease and was not involved in the studies. “The challenge is to move beyond laboratory experiments and understand its function in regulating the heart under physiological conditions,” he states.
“The findings do suggest that these nitrocatecholamines exist in the vascular wall and may have a functional role, but they still don’t tell us how significant that role is in controlling vessel relaxation in vivo,” adds cardiologist Francisco Laurindo, from USP’s Heart Institute (InCor), an expert in vascular system function.
6-ND also appears to play an important role in the genitourinary system. It is produced in the vas deferens, which transports sperm from the testicles to the urethra, and in the seminal vesicle, which produces semen. In these structures, 6-ND induces the contractions necessary for ejaculation. In the corpus cavernosum, it acts as a potent vasodilator. “We are revealing a new mechanism through which nitric oxide causes vasodilation. In addition to directly relaxing the vessels, NO, via 6-ND, inhibits the vasoconstrictive effect of dopamine,” says Britto Júnior, now a researcher at King’s College London in the UK.
Britto and the Campinas team are currently investigating the effects of another catecholamine they discovered in mammals: 6-cyanocatecholamine, which contains cyanide—a highly toxic compound. l
The projects and scientific articles referenced in this article are listed in the online version.
As illustrated in another Tabulae Anatomicae plate, the interior of the heart chambers produces compounds that regulate both the rhythm and the force of blood pumping

A surprising biological clock
Cyanobacteria live for approximately one day but can prepare themselves for seasonal changes
MARIA GUIMARÃES
Cultures maintained at 30 °C (Columns 1 & 3) compared with those immersed in ice water for two hours (Columns 2 & 4 ): those on the right were “warned” of the cold by winter lighting
It is difficult to imagine that the body (human or not) can react preventively on a much longer timescale than its own life, such as preparing physiologically for temperature forecasts for future centuries. However, this somewhat describes the behavior of strains of the cyanobacteria species Synechococcus elongatus used in laboratories; single-cell entities that live on light, performing photosynthesis, with a life cycle of approximately one day, according to Brazilian biologist Maria Luísa Jabbur, a researcher at the UK’s John Innes Center, whose article on the topic was published in September in the journal Science. When the bacteria are “warned” of the arriving winter, they quickly prepare themselves—even when the cold arrives several generations later.
Jabbur has studied the biological clock of these cyanobacteria since her undergraduate internship as part of the former Brazilian program Science without Frontiers at Vanderbilt University in the U.S. “Cyanobacteria are an excellent model for circadian rhythms, and for a long time, the focus of research into their biology was geared toward mechanistic and evolutionary aspects, which are much more easily studied in cyanobacteria than in eukaryotes,” she says. “I think that the photoperiodicity issue has been cast aside.” When this gap in studies into the internal clock of cyanobacteria became apparent over a longer time period, during her PhD back at Vanderbilt, she proposed an experiment to her advisor, U.S. biologist Carl Johnson, who in the 1990s was a participant in the identification of three genes (kai A, kai B, and kaiC) involved in the circadian clock of these organisms, together with Japanese biologists Takao Kondo and Masahiro Ishiura of Nagoya
University and U.S. molecular biologist
Susan Golden of the University of California, San Diego.
The proposal seemed absurd, but the researcher did not stifle the student’s creativity, keeping to a reminder on a Post-it note he had on the door of his office: “Progress is made by young scientists who carry out experiments that the old scientists said wouldn’t work.”
“Few reagents were needed; all I had to lose was my own time; I calculated that it would take between one and two weeks, so it was worth it,” recalls Jabbur. It worked the first time and took just a week to obtain a response in two Petri dishes, according to an article published in Quanta, a U.S. scientific journal, in October. Both showed the bacterial colonies as green spots and had been steeped in ice-cold water to simulate the arrival of winter, but one had been maintained in summer conditions, with more hours of light than dark, until it was exposed to the cold. The other contained descendants of a line of bacteria that had been “forewarned” of winter’s arrival by a change in the lighting conditions, which involved more hours of darkness. This latter dish had more abundant green
spots—unequivocal signs of survival and reproduction, creating more thrifty colonies. It seemed counterintuitive; after all, these organisms generate their own food from light.
The results led to a more detailed repeat of the experiment, with three groups of cyanobacteria exposed for eight days to different treatments, reflecting the well-defined seasons typically found in temperate zones: eight hours of light and sixteen hours of darkness every day, simulating winter; the same length of time for light and darkness, emulating mid-season; and sixteen hours of light as if it were summer, always at 30 degrees Celsius (°C), the preferred temperature for this bacteria. Under these conditions, the generations of microorganisms succeeded until the researcher collected samples that she placed on ice within small plastic tubes. “From time to time, I took a few drops from the middle of the culture with bacteria in ice and put them on new dishes to see how many cells had survived,” Jabbur recalls. Approximately five days later, the bacteria had reproduced sufficiently to enable counting of the green spots: they were three times more abundant in the group

A Post-it on Carl Johnson’s door empowered the student to conduct an unprecedented experiment
that received winter light, indicating that preceding generations may have adapted to cold conditions, even without being exposed to them. The project, which had been a side interest, became the key focus of her doctoral research, bringing her recognition in the field. “It’s a result that people associate with me.”
MODEL CLOCK
According to physicist Gisele Oda, coordinator of the Chronobiology Laboratory of the Institute of Biosciences at the University of São Paulo (IB-USP), the cyanobacteria played a central role in evolving knowledge of chronobiology by debunking, since the 1980s, the deep-seated notion that the biological clock would only be present in organisms with organized cell nuclei, which are absent in these microorganisms.
“They demonstrated that all living beings, even unicellular, with and without nuclei, have circadian rhythms,” recounts the researcher, who did not participate in the study but met Jabbur while an undergraduate at IB-USP.
Oda studies how subsurface rodents—tuco-tucos (Ctenomys flamarioni )—distinguish long days from short days even when they spend a large proportion of their time without seeing light.
“The cyanobacteria were even more surprising because they presented seasonality, and on top of that, they can determine that the day is longer in summer than in winter, with each specimen living less than a full day,” she says. “We thought that they would need to live at least 24
Cyanobacteria cultivated
to different light conditions to simulate the seasons
hours to conclude that day is longer than night in summer.”
Biologist Carlos Hotta, of the USP Institute of Chemistry (IQ), coordinates a group specializing in the investigation of circadian rhythms in plants and also expressed his surprise at the fact that bacteria have a mechanism to perceive such a long time frame. He did not participate in the study; he defines the cyanobacteria biological clock as completely different from that in other organisms, with a central oscillator that defines the rhythm based on only proteins and their interactions, in addition to having the resources to detect the environment and communicate that information to the organism.
Jabbur explained that this species has approximately 2,700 genes, including the three identified by Johnson and collaborators. Every day, kaiC undergoes a chemical process of gain and loss of phosphorus-containing molecules due to interactions between kaiA and kaiB. This phosphorylation and dephosphorylation movement is synchronized with day and night and occurs through cyclical chemical reactions that depend only on the proteins, without the need for continued activation or transcription of the genes.
From a laboratory standpoint, this protein-based chemical system means that simplified experiments may be conducted using test tubes, without the need for the cells themselves to be present. “That makes this system particularly good for chronobiological studies and allows us to stop the clock for part
of the cycle, for example,” says the researcher, who, after her PhD, went to work in the laboratory of British biologist Antony Dodd, who investigates how circadian regulation affects the adaptation of plants and microorganisms to environmental fluctuations.
She found that when exposed to short days, the cyanobacteria change the composition of their membranes, with folds in the phospholipids that make them less rigid, a process known as desaturation. “They do this proactively.” The more permeable membrane enables an increased exchange of molecules between the cells and the tissue, which aids in winter survival.
“For the plants, the capacity of foreseeing the seasons is essential and involves the definition of when to flower or shed leaves,” Hotta compares. Any living being that is not able to tell the time of day and season of the year is at an evolutionary disadvantage. However, to understand that an organism is prepared to deal with something that significantly exceeds its own lifespan, one needs to change the evolutionary standpoint to a view that natural selection acts upon the lineage and not on the individual bacteria, the article states in Science
This study highlights the notion of photoperiodism as a long-standing phenomenon and provides a model for studying its mechanisms and evolution. Indeed, cyanobacteria understand evolutionary seniority: this type of organism has existed for approximately 3.5 billion years and contributed to creating the possibility of life on earth by producing large quantities of oxygen through photosynthesis.
“We want to use cyanobacteria as a model to understand how photoperiodical responses can evolve in the face of climate change: basically subjecting them to similar conditions as projected for 2100 and seeing how they evolve after some years exposed to those conditions,” proposes Jabbur. Their solutions may, for example, guide the cultivation of food crops in a more productive manner. l
The scientific article consulted for this report is listed in the online version.
in Petri dishes were exposed
PHOTO LUÍSA JABBUR / JOHN INNES
AGRICULTURE
Native cassava farming
Farming by the Wauja people in Alto Xingu increases plant diversity and can help recover crops that have experienced genetic erosion
GILBERTO STAM
In a cassava field in the village of Ulupuwene, located in Alto Xingu, Mato Grosso State, an elder of the Wauja people pushes cuttings of different varieties of cassava into the ground, all of which are near one another. Each cutting sprouts leaves and roots. As they grow into bushy shrubs, the plants interbreed with each other. This cultivation technique stimulates the seed production of new varieties, preventing the genetic impoverishment typical of cloned plants, according to a study published in the journal Science in March.
“Cassava was domesticated by indigenous peoples approximately 6,000 years ago on the southern border of the Amazon, which today corresponds to the states of Rondônia and Mato Grosso,” says ethnobiologist Fábio Oliveira Freitas of the Genetic Resources and Biotechnology division at the Brazilian Agricultural Research Corporation (EMBRAPA), who led a team of researchers from eight countries. The cassava plant became so central to the diet that it was spread in the form of cuttings long before the colonial period through exchanges between neighboring communities ranging from the southern United States to the southern end of South America.

Welcome ritual in the village of Ulupuwene marks a partnership between indigenous people and scientists

The scientists arrived at this conclusion after analyzing the genomes of 282 cassava samples—both domesticated (Manihot esculenta) and wild (Manihot flabellifolia)—collected from living collections at research institutions or traditional farms, in addition to DNA extracted from herbarium collections and artifacts found at archaeological sites. They also used DNA data from 291 samples used in previous studies, analyzing a total of 573 genomes.
“Many traditional farmers, indigenous or not, identify the plants that sprout from seeds and let them grow,” says Freitas. If the plants have the qualities the farmers are looking for—such as a larger tuberous root or a higher starch content— they start using them as a source of cuttings, which form clones identical to the mother plant.
According to Freitas, the shrub can also crossbreed with wild species found near the farms, increasing variability in the genome.
“As a result of cloning, all cassava plants in the Americas have the same genetic markers of kinship, as if they were siblings,” says British biologist Robin Allaby of the University of Warwick, UK, one of the authors of the article. In a conversation with Pesquisa FAPESP, he highlighted that the pattern differs from that of crops such as corn, which form distinct lineages.
“The study involved a comprehensive genetic analysis of cassava, confirming genetic patterns that were observed in other more limited studies,” says Nivaldo Peroni, an ethnobiologist from the Federal University of Santa Catarina (UFSC), who did not participate in the research. “However, it could have placed a greater emphasis on the important role that non-indigenous traditional communities played in generating di-


versity—not only in the Amazon, but elsewhere in Brazil and the Americas.”
According to Peroni, there are more than 7,000 varieties of cassava, created by communities with their own preferences when plants are selected. Researchers have studied the origin and circulation of varieties in traditional Brazilian communities and highlight that farmers of Azorean origin living on the Atlantic coast in the central–south region of the country, such as in the state of Santa Catarina, learned how to cultivate cassava from local indigenous peoples.
“In the south, extremely white varieties predominate, reflecting the desire to produce something similar to European wheat flour,” adds Peroni. On the coast of the state of São Paulo, he found more than 50 varieties in the municipality of Cananéia and more than 30 in Ubatuba, each with their own characteristics. Many of these varieties were generated from sprouting seeds in the farms and gardens of caiçara communities.
Because cassava is rich in nutrients and easy to reproduce and transport, the tuber has become one of the main food items for indigenous people and is part of the diet of one billion people worldwide, according to the UN Food and Agriculture Organization (FAO).
Freitas and Allaby visited the village of Ulupuwene several times between 2018 and 2023 to



investigate traditional cassava farming methods, collect samples of different varieties, and interview residents. “It is a unique technique, mastered by just a few families,” says Freitas, who has been studying Wauja agriculture since 1997.
After preparing the land, the indigenous people form mounds of loose earth to make it easier to harvest the tubers later and then stick cuttings into the mounds. These cuttings represent elements of a cassava farming legend: they call the set of branches a Kukurro house, in honor of their caterpillar god, who eats cassava leaves. They believe that the plant’s growth is strengthened by ritual chants to Kukurro. The seeds formed by this mixture of plants are important sources of genetic variety and usually remain dormant until germination is stimulated the following year by fires used to clear the land before crop planting.
“Women play a crucial role in this process,” explains UFSC biologist Carolina Levis, who did not participate in the study. “They are usually the ones responsible for taking care of the crops. They are curious and let new plants grow, observing their characteristics.”
“The Wauja are very selective,” adds Freitas. “They chose four varieties that originated from seeds during our visits but discarded them all after deciding that they did not have any new characteristics.” If a new plant is approved, they name it and incorporate it into the village's live collection.
The video Casa de Kukurro (Kukurro house), produced by EMBRAPA in 2019 and available on
YouTube, shows the ritual that accompanies the planting process. The Wauja are not concerned with the caterpillars that eat the cassava leaves: in the village's mythology, it is Kukurro who feeds and takes care of the plants. Seedlings that grow from seeds are called kukurromalacati and are considered plants that fall from the sky.
“We identified 19 varieties of bitter cassava in Ulupuwene,” says Allaby. According to researchers, unlike sweet cassava varieties, bitter tubers can be lethal if not properly processed to eliminate the hydrocyanic acid, which is toxic. “You need to peel the root, grate and press the pulp, boil it to evaporate the hydrocyanic acid, and then put the cassava starch in the sun to dry,” says Freitas. The starch is used to make biju, the main component of the Wauja diet, alongside fish.
When women marry, they often take their family's plant collection with them when they move to live with their husband and then continue to exchange plants with relatives when they return to visit. “Marriage can be interethnic and can involve great distances, increasing the circulation of cuttings,” adds Levis.
“The study shows how important small-scale agriculture is to food security,” says Allaby. He points out that of the 20 varieties of banana that exist in Brazil, only the nanica—which is genetically deteriorating and could disappear in a matter of decades—can withstand being transported to Europe by ship. “Indigenous people know much more about cassava farming than we do,” he acknowledges. According to him, the Kukurro house is a technique that can help genetically rejuvenate the diversity of cassava and other plants, representing an important example of how academic science can benefit from exchanges with the science of indigenous and traditional peoples. l
Elder Kuratu Wauja builds a Kukurro house by planting cassava cuttings
In-depth field insight

Drone-based radar facilitates crop monitoring, soil analysis, and the identification of underground mineral deposits, anthills, and bones
DANILO ALBERGARIA

To capture a broad view of the terrain, radar equipment is positioned on the underside
In agriculture, drones are used to distribute seeds or fertilizers with precision, saving both time and money. When combined with sensors and artificial intelligence, they can be used to perform remote sensing, similar to satellites and airplanes, monitor large crops, conduct detailed analyses of soil chemical elements, and identify issues such as erosion. One of the most advanced techniques in this field, synthetic aperture radar (SAR) was enhanced by Radaz, a startup founded in 2017 at the University of Campinas (UNICAMP) that is now based in São José dos Campos, São Paulo.
“It’s an innovative technology with enormous potential to generate a wide variety of products, serving various market segments,” says electrical engineer Hugo Enrique Hernández Figueroa from UNICAMP’s School of Electrical and Computer Engineering (FEEC), who led the team responsible for developing radar equipment for mounting on a small drone. To achieve this, the team had to miniaturize the radar’s electronic hardware and antennas. The idea behind SAR involves using a moving radar to simulate an antenna significantly larger than the physical components of the radar. As the antenna’s directivity increases with its size, the system’s resolution also improves.
Through its antenna, the radar emits pulsed electromagnetic waves that are reflected by obstacles on the ground. The waves are then detected by the antenna while the radar is in motion, whether on an airplane, satellite, or drone. The movement of the radar along its trajectory creates a large virtual antenna, allowing for high resolution and precise observations.
The operating principle of SAR is similar to that of interferometry, where the combination of multiple radio antennas simulates a single large antenna corresponding to the path traveled. If the drone moves 100 meters (m) in a straight line, the SAR can simulate a 100-meter aperture antenna; if the trajectory is circular, with a radius of 300 meters, the radar will simulate a spiral-shaped antenna with a 300-meter radius.
Developed in the United States in the 1950s and used in satellites and space probes since the 1960s, SAR has been employed to map the terrain of Venus, which is obscured by clouds made of microscopic drops of sulfuric acid and other aerosols. In the early 2000s, SAR was integrated into large drones for military purposes. With the growing miniaturization of electronic components and the proliferation of drones, it has become apparent that SAR systems can be attached to small, civilian devices.
“The challenge was to do it, and nobody was doing it,” says Figueroa. The first recorded instance of SAR on a drone dates to 2016, at the University of Texas, United States, but this version was handmade and produced low-quality images. The São Paulo-based company took a different approach, developing a system with three spectral bands, including an advanced inertial navigation system (see infographic).
Working with his team, the UNICAMP researcher focused on reducing the size of a 100-kilogram (kg) device, only usable with airplanes, to one weighing 5 kg that could fit on small drones. Electronic engineer Laila Moreira, technical director of Radaz and a key contributor to the device's development at UNICAMP, notes that another critical modification was the in -
of the drone
corporation of computer programs designed for processing and interpreting the images, which were based on artificial neural networks.
FAPESP’s support through the Innovative Research in Small Businesses (PIPE) program helped transform the prototype, completed in 2017, into a commercial device. The first results from monitoring of eucalyptus and sugarcane crops were published in February and April 2020 in the journal Remote Sensing.
The drone primarily follows two flight paths, namely, linear, in a single direction, and helical, in the form of a downward spiral, simulating a parabolic antenna to increase the radar resolution. The pulses emitted by the radar along the helical path and reflected by different underground structures provide precise data about the
Precise view
The synthetic aperture radar is equipped with three antennas operating in different spectral bands
C-Band
Collects data on the top of the vegetation and provides information on its growth
L-Band
Capable of crossing the treetops, it can measure crop volume. In helical flight, it can capture information about the soil
P-Band
Penetrates the soil and can extract information up to 50 cm deep in linear flight and up to 100 m deep in helical flight
subsoil. This information is processed using the back-projection algorithm, typically used in CT scans, which reconstructs the reflected pulses into three-dimensional images.
The device is equipped with three antennas, each operating on a different band. The C-band collects information about the top of the vegetation and provides data on plant growth. The L-band penetrates beneath the treetops to measure the volume of a crop or, in helical flight, to capture data about the soil. The P-band penetrates the soil, extracting information up to 50 cm deep in linear flight and up to 100 m deep in helical flight. According to Radaz, no other device in the world has this configuration.
In a field test conducted in 2022, the P-band successfully detected leaf-cutter ant nests in eucalyptus and pine crops owned by paper manufacturer Klabin in Paraná. The equipment identified 29 previously unknown anthills, with areas ranging from 1 to 100 square meters (m²), in a eucalyptus crop in Ortigueira, Paraná. The device showed that the ant nests were located at depths of up to 7 meters, as detailed in a preprint article submitted to the arXiv repository in December 2024.
“This was the world’s first record of an anthill underground using this technology,” said Bruno Afonso Magro, Klabin's forestry research and development manager, in an interview with Agência FAPESP in July 2022. Typically monitored through area sampling and human intervention, leaf-cutter ants create nests that can reduce productivity by up to 15%.
In another test, which was published in December 2024 on arXiv, the equipment successfully identified the height and growth stage of 340 sugarcane seedlings planted in a 20,000 m² experimental area at UNICAMP’s School of Agricultural Engineering (FEAGRI). A report presented at a congress in Athens, Greece, in 2024 showed that the device achieved 100% accuracy in locating cow and pig carcasses buried 1.5 meters underground. The device can also record soil subsidence, erosion, and humidity.
FOREIGN DEMAND
The Radaz system has also been successfully used to monitor the growth of sugarcane on a farm in São Paulo and to locate iron ore deposits, according to electronic engineer Fernando Ikedo, Radaz's commercial director. Owing to contractual stipulations, the names of the clients cannot be disclosed.
The market for remote sensing with drones appears to have significant growth potential.


According to Ikedo, the startup's revenue increased from R$1.1 million in 2022 to R$5.1 million the following year. In 2024, it reached R$17.3 million, with most of the revenue coming from international sales.
One of the clients is physicist Henrik Persson from the Swedish University of Agricultural Sciences, who uses a radar-equipped drone to assess the biomass and metabolism of trees, soil moisture, water tables, and underground rock layers. “The tomographic measurements have enabled new research into soil conditions, usually done by taking samples, which is expensive, tedious, and time-consuming,” Pesquisa FAPESP reported.
The British company Surveyar acquired the innovative technology to map beaver dams, which cause losses to farmers by damming up waterways and flooding crops. According to the company’s director, William Kirk—who discovered Radaz while reading articles by Brazilian researchers on anthill detection—the experiment was successful and led to the use of the technology for detecting soil and vegetation moisture, monitoring soil deformation, measuring biomass, and identifying buried objects.
CHALLENGES AHEAD
With no similar equipment available on the domestic market, the new technology faces the challenge of exploring new markets. Given the cost of the electronic components and the advanced technology involved, the complete equipment is sold for no less than R$1 million, excluding the cost of the drone. There are also other complementary technologies that are more affordable and can meet the specific needs of rural farmers, although none offer the same capabilities as the Radaz device does.
Depending on the objective, crop monitoring can be conducted with simple conventional cameras, such as RGB cameras, which capture only the visible spectrum and are priced between R$12,000 and R$60,000. Multispectral cameras, which cover other frequencies, such as infrared, can cost up to US$300,000 (approximately R$1.6 million). Devices of this type can provide satisfactory data on plant growth, biomass, and health status, according to environmental engineer Lucas Osco from the University of Western São Paulo (UNOESTE) and the Instrumentation unit of the Brazilian Agricultural Research Corporation (EMBRAPA) in São Carlos, who works with remote sensing.
Another alternative, according to Osco, is light detection and ranging (Lidar) technology, which uses laser beams instead of radar signals. With prices starting at R$100,000 and reaching R$1 million, it offers detailed three-dimensional mapping but has visibility limitations, leaving room for the use of SAR.
Innovative technology aimed at use in the field also faces challenges related to regulation and operator training. Additionally, there is resistance from Brazilian farmers, who, in the recent past, have seen results below expectations from drones that promised to increase production. “Farmers opt for technologies that are already established, with high and guaranteed returns. This makes it difficult to sell innovative products,” notes agricultural engineer José Marques Júnior, from São Paulo State University (UNESP) Jaboticabal campus, a specialist in soil analysis. l
Close-up images of the device attached to a drone (on the right) and the radar being tested in the startup’s laboratories
From the forest to the air

Upon descending close to the surface, aerosol particles formed by isoprene gas generate cloud condensation nuclei

Gas emitted by trees in Amazonia increases the production of condensation nuclei, the origin of clouds, by 100 times
MARCOS PIVETTA
Adefense mechanism that has emerged and disappeared several times over the evolutionary history of different lines of plants, particularly trees in hot environments, involves the number of clouds in the sky and plays a crucial role in Amazonia as one of the most important land climate parameters. Most likely developed as a way of dealing with thermal stress peaks, tree foliage emits a volatile compound— isoprene gas (C₅H₈). Under daylight sun, isoprene degrades rapidly after being released, but under certain nocturnal conditions, the compound remains in the air for longer periods, increasing in altitude and transforming into an essential component of atmospheric chemistry: a type of diffuser of the processes that result in clouds. This is the primary conclusion of two new studies conducted by international groups with the participation of Brazilians published simultaneously in the journal Nature in December.
A molecule of the terpene family, which comprises the primary volatile compounds emitted by plants, isoprene reacts with other gases when released by tree foliage, escaping a premature end and causing a series of reactions in the lower and higher troposphere, the most superficial layer of the Earth’s atmosphere. These interactions multiply the rate of aerosol particle formation by more than tenfold, resulting in condensation nuclei, the “embryo” of clouds. This mechanism not only increases the generation of clouds over Amazonia but also over the Atlantic Ocean as well as other parts of the planet. Approximate -
ly two-thirds of the Earth’s surface has permanent cloud coverage, a climate aspect that can both heat and cool a region while also resulting in moisture through rainfall.
The articles provide a detailed look at the sequence of physical-chemical interactions between isoprene and other compounds that lead to the formation of enormous quantities of aerosol particles in the high Amazonian troposphere at altitudes between 8 and 15 km (km). These particles initially measure a few nanometers (nm) in diameter, clustering with other aerosols and growing in size over time. They can be transported to different parts of the globe by atmospheric circulation and play important roles in the origin of cloud condensation nuclei. When they reach the lower troposphere, which is between 1 and 2 km in altitude, nuclei that are at least 50 nm in diameter function as water vapor supports, which condense (become liquid) and generate clouds. Without these nuclei, there are no clouds, which can be both fair weather and rainfall.
The discovery of these interactions initiated by the emission of isoprene, which becomes a gas at temperatures in excess of 34 degrees Celsius (°C), explains a phenomenon observed for two decades in the Amazonian skies. At the early 2000s, researchers became aware of the existence of aerosol concentrations in the high tropical forest troposphere that were 160 times greater than those measured close to the surface. However, there was no consistent explanation for these findings until the new studies were published. “We have now solved this mystery and have demonstrated that an organic compound released by
the forest—isoprene—initiates the formation process of these aerosols,” says physicist Paulo Artaxo of the University of São Paulo’s Institute of Physics (IF-USP), coauthor of one of the studies, both referenced on the cover of Nature. “It’s very important for us to understand the cloud formation process to improve our weather and climate forecast models.”
One of the articles is based on chemical process data obtained from overflights in Amazonia via the Halo aircraft of the German Aerospace Center (DLR) between December 2022 and January 2023, part of the Chemistry of the Atmosphere: Field Experiment in Brazil (CAFE-BRAZIL) project, a field study conducted two years ago. “We overflew for 136 hours and clocked up 89,000 km over Amazonia,” says meteorologist Luiz Augusto Machado of IF-USP, a collaborator
From the trees to the skies
Isoprene gas released by the forest ascends to the high atmosphere and accelerates the formation of condensation nuclei, which then descend close to the surface and generate clouds
at the Max Planck Institute for Chemistry in Germany, who supervised all the flights and crewed on some. The Halo aircraft took off from Manaus, the Amazonas state capital, before sunrise to capture the physical‒chemical interactions of isoprene without the influence of sunlight, with a continuous range of 10 hours to record atmospheric parameters.
The second study was conducted at the European Organization for Nuclear Research (CERN) in Switzerland, using the CLOUD (Cosmics Leaving Outdoor Droplets) chamber. This device reproduces atmospheric conditions and processes. “CLOUD is a 3 m-high stainless-steel cylinder supplied with ultraclean air in the same proportions of nitrogen and oxygen that we have in the atmosphere,” explains Brazilian meteorologist Gabriela Unfer, currently undertaking her
3 Between 8 and 15 km in altitude, at a temperature of -30 oC, isoprene reacts with NOx during the day under the effect of ultraviolet radiation
4 C₅H₈ and NOx interact with acid compounds and generate particles a few nanometers (nm) in size, which grow and lose altitude over time
2 At night, the gas molecules are transported upward in deep convective clouds, whose rays generate nitrogen oxides (NOx)
1 Tree foliage releases the gas isoprene (C₅H₈) in response to heat effects
5 When they grow larger than 50 nm, the aerosols, which are then close to the surface, become condensation nuclei in which water vapor is supported to generate clouds
PhD at the Leibniz Institute for Tropospheric Research in Leipzig, Germany, and the only Brazilian authoring the articles on high-altitude aerosols.
To enable the CLOUD system to simulate atmospheric conditions in a certain region of the planet, area-specific meteorological and chemical information needs to be input. “The field data obtained during flights in the CAFE-BRAZIL program formed the basis for the correct configurations of temperature, moisture, and gas concentration to be simulated by CLOUD. This is how we reproduced, in the laboratory, the formation of high-altitude aerosols brought about by plant isoprene emissions,” explains Unfer.
The most surprising aspect of the studies is that the aerosols formed between 8 and 15 km in altitude are due to processes that commence among the trees of Amazonia. “If the tropical forest continues to be stripped, this will have an impact on the aerosol production process in the high troposphere, and consequently on the formation of clouds closer to the surface,” says Micael Amore Cecchini of the Institute of Astronomy, Geophysics, and Atmospheric Sciences at the University of São Paulo (IAG-USP), another author of one of the papers, who participated in the CAFE-BRAZIL campaign.
The key to the entire process is isoprene, a volatile, colorless organic compound with a very slight aroma that may be referred to as rubber or petroleum. The release of this gaseous molecule, expelled as a type of vegetation transpiration, is an evolutionary mechanism that helps plants, particularly those in the tropics, protect themselves from the negative effects of heat peaks. Close to the surface, in the low atmosphere, isoprene can last for minutes or a few hours. During sunlight hours, it reacts with ozone and other compounds and quickly disappears, almost completely, from the atmosphere.
However, isoprene molecules are not destroyed, and those emitted after sundown by Amazonian trees escape this premature end and are transported into the high atmosphere by the action of night storms. At approximately 15 km in altitude, where the temperature is lower than -30 °C, isoprene does not degrade as it does close to the surface, and it interacts with other compounds. Nighttime storm rays cause isoprene to bond to nitrogen oxide molecules, quickly forming an enormous number of aerosol particles a few nanometers in size. “In the high atmosphere, isoprene accelerates the speed of aerosol formation by 100 times,” comments

Machado. The speed of aerosol movement in the high troposphere can reach 150 km per hour. It is therefore reasonable to suggest that aerosols migrate to regions very distant from Amazonia, where they lose altitude and bond until they form cloud condensation nuclei between 1 and 2 km above the Earth’s surface.
It is likely that this aerosol formation mechanism at high altitudes also occurs in other regions of the globe, especially over the tropical forests of the Congo, Africa, and southeastern Asia. Isoprene is the primary volatile compound emitted by vegetation. Approximately 600 million tons are released into the atmosphere every year. “This type of aerosol particle formation in the high troposphere probably happens not only in Amazonia, but in all tropical forests, given that they all emit large amounts of isoprene,” meteorologist Joachim Curtius of the University of Frankfurt, lead author of the study on data from the CAFE-BRAZIL experiment, said in an interview for Pesquisa FAPESP. “The Amazon forest alone is responsible for more than a quarter of total isoprene emissions.”
The next step in the research will elucidate how the growth and transportation of aerosols occur in the high Amazonian troposphere and how they descend close to the Earth’s surface. “We don’t know how many of these particles are lost by collisions with other particles, and in other interactions, nor how they ‘survive’ and become condensation nuclei in the low altitudes of the tropics, where clouds form,” says Curtius. In this process, isoprene is just the tip of the iceberg—or rather, the cloud. l
A Halo aircraft overflies Amazonia to obtain atmospheric chemistry measurements The
Triple suffocation in the ocean

Compound extreme events consisting of heatwaves, high acidification, and chlorophyll scarcity have become frequent in the South Atlantic since 2009
RENATA FONTANETTO
Atriple extreme event that was virtually unheard of in the South Atlantic 20 years ago—a combination of marine heatwaves, chlorophyll shortages, and severe sea acidification—has begun to occur more frequently in the subequatorial region of the ocean since 2009, according to an article published in the journal Nature Communications on April 16. This is the first study to map the frequency and intensity of this compound phenomenon in this area of the Atlantic.
The event occurrence was analyzed over two consecutive 10-year periods (from 1999 to 2008
and 2009 to 2018) in six regions of the South Atlantic: three near the Brazilian coast and three off the coast of Africa. In the first time period, there was no record of all three extremes occurring simultaneously in any of the six areas. In the second period, the story changed completely. Triple event episodes began to emerge and became relatively common. Depending on the region, the minimum cumulative duration of the three events ranged from 17 to 49 months in the second decade covered by the study (see comparative table on Page 50). The most severe episodes, combining heatwaves, high acidity, and low chlorophyll availability, covered areas representing between 4% and 18% of the total area of each region.
“Starting in 2016, the triple phenomenon began to occur almost every year,” says physical oceanographer Regina Rodrigues of the Federal University of Santa Catarina (UFSC), lead author of the article. According to the study, the summer of 2015–2016 was exceptional in terms of the intensity and spatial coverage of triple compound events in the six regions studied.
The areas analyzed in the western Atlantic, near the Brazilian coast, were the Equatorial Atlantic (off the coast of Northeast Brazil), the Subtropical Atlantic (Southeast Brazil), and the Brazil–Falkland Confluence (southern Brazil).
On the eastern side, off the coast of Africa, the regions known as the Eastern Equatorial Atlantic (near Nigeria, Cameroon, and Gabon), the Angola Front (off the coast of Angola and Namibia), and the Agulhas Leakage (southwest of South Africa) were investigated.
Intense climate disturbances that occur in these areas can affect local fishing and mariculture. Warmer, more acidic water increases the mortality of marine species and causes coral bleaching, which is an indicator of enormous

stress. A low level of marine chlorophyll, a natural green pigment essential for photosynthesis in plants and algae, indicates a reduction in the availability of phytoplankton, which are essential to the diets of many marine organisms.
To be classified as a triple event, all three of the extreme phenomena must occur simultaneously in at least 1% of the area of interest. This study focused its analysis on the summer months, from December to March. The incidence of heatwaves in the South Atlantic was determined on the basis of information from the U.S. National Oceanic and Atmospheric Administration (NOAA). The occurrence of extreme high-acidity events was obtained from data from the Met Office Hadley Centre, UK. Extremely low concentrations of chlorophyll in the South Atlantic were inferred from a NASA model that calculates the concentration of natural green pigments in the oceans.
Oceanographer Leticia Cotrim of the State University of Rio de Janeiro (UERJ), who did not participate in the study, believes the article is unique in that it presents data on the frequency and extent of extreme marine events that consist of three concomitant changes. “It is an innovative study. Previous research has only analyzed one type of extreme event in isolation, or two together at most, and usually in other oceans rather than the South Atlantic,” says Cotrim. “The results of this study could be used by ocean conservation projects, in addition to serving as a guide for economic activities that depend on the sea.”
One concern raised by the study is the increase in the acidification process in the South Atlantic. Between 1998 and 2008, the phenomenon was practically nonexistent in this part of the ocean, with the exception of two locations further north, near the African continent. Since 2009, the South Atlantic has become much more acidic. This change is linked to the rising average global temperature in recent decades caused by the increase in greenhouse gas emissions, such as carbon dioxide (CO₂) and methane (CH₄), which are heating up the planet. “We are seeing increasingly frequent episodes of marine acidification. This trend appears to have increased the occurrence of these triple compound events over the past 10 years,” oceanographer Thomas Frölicher of the University of Bern in Switzerland, another author of the article, said in an interview with Pesquisa FAPESP.
The Earth's climate, which has warmed by approximately 1.5 degrees Celsius (°C) since the
Aerial view of corals bleached during a 2020 heatwave in the Rio do Fogo region of the state of Rio Grande do Norte. Close-up: underwater image of coral that has lost its color
Escalation of triple extreme events
Simultaneous occurrence of marine heatwaves, severe acidification, and chlorophyll scarcity in the South Atlantic between 2009 and 2018
Total duration of triple events
Proportion of the region affected by the phenomenon
mid-nineteenth century because of greenhouse gas emissions from anthropogenic activities, would be even hotter today without oceans. They absorb 90% of the heat from the Earth's atmosphere and 30% of CO₂ emissions, but these environmental services come at a cost to the seas. Absorbing most of the Earth's heat leads to marine heatwaves. Removing almost one-third of greenhouse gases makes the water more acidic.
In years in which El Niño occurs, a phenomenon characterized by abnormal warming of surface waters in the central and eastern equatorial Pacific Ocean, all of this intensifies. The change in climate triggers alterations in the atmosphere that interact with oceanic conditions. “El Niño acts as a remote agent on the local factors we observed. The incidence of triple extreme events in the six regions of the South Atlantic is therefore higher in El Niño years, such as 2015 and 2016,” explains Rodrigues.
In another article coauthored by the UFSC researcher, published in the journal Communications Earth & Environment in March 2025, heatwaves alone were shown to be sufficient to cause extensive damage to coral reefs in areas near the equator, even at times when there is no sharp increase in marine acidity. In very warm waters and with other stress factors, such as excess sunlight, corals expel the algae that give them their color, known as bleaching. Since the 1980s, this type of extreme event has become 5.1 times more frequent
and 4.7 times more intense in the tropical waters of the North and South Atlantic.
One recent episode that attracted attention was a severe marine heatwave that occurred near Rio do Fogo, a coastal town in the Brazilian state of Rio Grande do Norte, in the summer and autumn of 2020. Rising water temperatures in the region resulted in the bleaching of 85% of hard corals and 70% of zoanthids (softer-bodied organisms that inhabit reefs). “The water reached 32 °C—the normal summer temperature there is 28 °C,” says biologist Guilherme Longo of the Federal University of Rio Grande do Norte (UFRN), another author of the article. “Several coral species in the region have an average thermal limit of 29.7 °C. If exposed to temperatures above this threshold, they begin to suffer biological damage.”
According to Longo, heatwaves have increased in frequency, intensity, and scale, affecting more areas along the northeastern coastline. In 2024, the hottest year in the planet’s recent history, the region was affected by an unprecedented extreme thermal event. “The extent of the phenomenon and species mortality were slightly greater last year than in 2020. Many species had just come out of a very intense period of disturbance and were then subjected to another one,” says the biologist. With global warming on the rise, new negative records are expected to be set in the Atlantic. l
SOURCE REGINA RODRIGUES
The light of sound
Controlling interactions between photons and phonons could generate more refined lasers and facilitate quantum information processing
DANILO ALBERGARIA
The drawing shows the cavity inside the optomechanical crystal, where light waves (in red ) interact with mechanical waves in the structure. This interaction produces two beams of light that travel in opposite directions: one pink beam and one blue beam
When it propagates through a material, a laser beam of significant intensity slightly modifies the density of the physical medium and generates small vibrations. These acoustic oscillations distort the material and can alter the original characteristics of the light beam. Two recent scientific articles to which Brazilian physicists contributed presented the experimental progress in controlling the interactions between light waves (photons) and acoustic or mechanical waves (pho-
nons) within a physical medium. This phenomenon is briefly described above.
“The papers describe advancements that could facilitate the development of devices for quantum communication systems,” said Gustavo Wiederhecker of the Gleb Wataghin Physics Institute at the University of Campinas (IFGW-UNICAMP). Wiederhecker coauthored one of the articles and heads the QuTIa Quantum Technologies Program at FAPESP, under which the two studies were performed.
The first article, which was published in Nature Communications on March 15, presents a silicon crystal that is designed to very quickly dissipate heat and increase efficiency when information based on qubits (quantum bits) is processed. The second article, which was published in Physical Review Letters on March 21, reported a new strategy for manipulating the polarization of light, indicating the (vertical or horizontal) plane on which its electromagnetic waves vibrate. This advancement could be useful for producing thinner, purer laser beams, which could theoretically increase the data transmission capacity in optical fibers.
Both studies were conducted by physicists from UNICAMP in partnership with American universities. Despite different approaches, both studies have contributed to the development of optical devices that can perform quantum transduction through acoustic oscillations. The process uses mechanical vibrations to convert quantum information between two forms of energy, from one wavelength of the electromagnetic spectrum to another. To create a quantum network, qubits encoded in microwave frequencies must be converted to quantum bits that work with visible light, without significant loss of information.
This is the focal point of the Nature Communications article, which suggests that quantum transduction can be performed using a silicon crystal with which light can interact along a plane in two dimensions. Until now, transducers have always been crystals whose structure allows for interactions with light in one dimension, but only in a given direction. The disadvantage of these one-dimensional crystals is their propensity for residual heating. The material absorbs some of the light energy, making the transduction process less efficient. “Our crystal was designed to 'talk' to the superconducting qubits and to dissipate heat very quickly,” explains Thiago Alegre of IFGW-UNICAMP. He coauthored the paper with André Primo, who completed his PhD un-
der Alegre’s supervision in 2024, and colleagues from Stanford University, USA.
To control the increase in temperature, researchers designed a two-dimensional optomechanical crystal with structures referred to as “boomerangs” and “daggers.” Boomerangs, which are more external, function as shields against interactions between the crystal and the environment, preventing mechanical disturbance. The more internal dagger structures trap the light inserted into the crystal with an optical fiber. In addition to confining the photons, the daggers also vibrate, generating acoustic waves. The phonons arising from this vibration interact with the photons between the daggers and connect to them. Owing to this quantum coupling, any change in the state of the photons causes an almost instantaneous change in the phonons, and vice versa. The result is that within this device, it is possible to convert information contained in light to acoustic vibrations.
Transmitting information between quantum processors typically requires superconducting materials that operate at microwave frequencies and extremely low temperatures, near absolute zero (-273.15 degrees Celsius). A microwave transmission line between these devices would have to operate at similar temperatures, because at these frequencies, quantum information becomes disorganized at higher temperatures. In practice, the cooling required to build longer quantum networks of more than a few meters hits a thermal barrier.
The geometry of the crystal proposed by UNICAMP and its partners overcomes the problem of residual heating, but it still needs to be refined so that it can handle the conversion of quantum information from one form of energy to another. The team has not been able to fully control the acoustic vibrations of the crystal during the process of converting data from microwave frequencies to visible light frequencies. If this goal can be achieved, it will be possible to transmit quantum data via lasers over extensive fiber optic networks. “Fibers are excellent thermal insulators, and information carried by light is not disturbed by temperature variations,” stated Primo.
Anderson Gomes, a physicist from the Federal University of Pernambuco who did not participate in the study, reported that the research is highly original. “It extends the frontier of knowledge in optomechanics,” he said. “It is the first step toward demonstrating transduction with a two-dimensional silicon crystal.”
The second article addresses a phenomenon known as Brillouin scattering, which occurs when the properties of a light shining on a medium are altered due to the effect of the material’s

acoustic vibrations. The result of this interaction between photons and phonons is that the scattered light can have a different frequency (color) than the incident light. In the field of communications, the manipulation of this type of scattering, which was proposed in 1922 by the French physicist Léon Brillouin (1889–1969), is currently used to measure temperature and pressure in optical fibers.
In the article published in Physical Review Letters, physicists directed a laser beam into lithium niobate (LiNbO₃) waveguides to change the polarization of light (the plane on which its electromagnetic waves vibrate). This type of alteration can produce purer, finer lasers, which tend to be more efficient at transmitting information. Waveguides are structures that confine and direct the propagation of electromagnetic waves (usually lasers) or mechanical vibrations.
Lithium niobate, a material often used in telecommunications, has a microscopic hexagonal structure similar to a honeycomb and is anisotropic; that is, any changes in the orientation of its structure affects the way it interacts with light. Waveguides are typically constructed from isotropic materials such as silicon nitride (Si₃N₄), which interact with electromagnetic radiation in the same way regardless of the orientation of their structures.
In addition to being anisotropic, lithium niobate was chosen for the experiments because of another desirable characteristic: it is piezoelec-
tric; that is, it produces electrical charges when it vibrates or is subjected to mechanical stress. Experiments performed at the Integrated Photonics Laboratory of the IFGW indicate that changing the incline of a LiNbO₃ waveguide alters the intensity of light scattering. The electromagnetic frequency of the scattered waves also relies on the wave scattering angle.
In lithium niobate waveguides, light interacting with vibrations is scattered in cross-polarization. If the initial laser beam is horizontal, the light reflected by the phonons of the physical medium is vertically polarized and vice versa. “This way of manipulating the information transmitted by light could be useful for manufacturing waveguides that function as polarization converters,” notes the study’s lead author, physicist Caique Rodrigues, who completed his PhD at UNICAMP in early 2025, supervised by Wiederhecker. Rodrigues coauthored the paper with Wiederhecker, Alegre, and four other researchers from the UNICAMP optics group, as well as colleagues from Harvard University, USA.
Cleber Mendonça, a physicist from the São Carlos Physics Institute at the University of São Paulo (IFSC-USP) who did not participate in the study, suggests that the results reinforce the possibility that the polarization of light could be manipulated with something similar to an optical key. “It could thus be possible to select the light polarization that would or would not propagate inside optical fibers,” he remarked. l
Image of a waveguide created at UNICAMP (black rectangle) and attached to two optical fibers
Microwaves to hunt tumors
New generation of imaging systems will avoid the breast compression and radiation of traditional mammography
GISELLE SOARES
Information engineer Bruno Sanches carefully places an orange, conical apparatus 15 centimeters (cm) in diameter, which looks similar to the cup of a brassiere, on the table at the University of São Paulo Polytechnic School’s Integrated Systems Laboratory (POLI-USP). This is not without good reason: the apparatus is the prototype of a new generation of examination devices that adjust around the breast and capture images at different angles to search for tumors that need to be removed. The Brazilian National Cancer Institute (INCA) estimated 73,600 new cases of breast cancer per year in the country between 2023 and 2025. Breast cancer is the most common tumor among women across all regions of Brazil, with the highest rates in the country’s south and southeast regions.
The key characteristic of the new imaging system, a joint project between POLI-USP and the Electrical Engineering Department at the Federal Institute of São Paulo (IFSP), is its microwave function, a new technological approach also studied at universities in the US, Canada, the UK, Sweden, Italy, Japan, and Australia. The mammography devices currently used to detect


breast tumors use X-rays, a type of ionizing radiation that can present risks to health.
Although well tolerated by most women, traditional scans can cause discomfort and pain as the equipment’s plates compress the breasts. The new device designed by the São Paulo researchers molds to the breast shape and avoids the current painful process. In 2023, 4.4 million mammograms were conducted by the Brazilian Public Health System (SUS).
“We want to offer a complementary alternative to mammography,” says Sanches. The engineer believes that the device could be especially useful among women with denser breasts, for which mammography is less sensitive. Density is not related to size but is the proportion of fibrous and glandular tissue in relation to adipose (fat) tissue.
The standard of the American Radiology College (ACR) for imaging scans is to classify the breasts into four density categories: those that are predominantly fatty and less dense, which are easier to scan by mammography; those with sparse areas of fibroglandular tissue; those that are heterogeneously dense, which may hinder the detection of small nodules or tumors; and those that are extremely dense, making the identification of lesions on the mammograph even more difficult. The proposed system may be advantageous for dense breasts, as the electromagnetic properties of the tissues involved are discrepant and can be differentiated.
“The denser the breast, the whiter it appears on the mammogram, making it difficult to identify tumors, which are also white,” explains radiologist physician Almir Bitencourt of São Paulo’s A.C. Camargo Cancer Center, a leading Brazilian facility for research, diagnosis, and treatment in the area. “In these situations, complementary exams such as ultrasound or magnetic resonance imaging (MRI) are normally recommended.”
RADIO WAVES
The prototype developed by USP and IFSP uses an electronic device known as a microwave transceiver that transmits and receives signals through embedded antennae. The transceiver emits ultrabroadband radio waves at a central frequency of 6.4 gigahertz (GHz), which pass through the mammary tissue and return to the device if they encounter denser internal structures, such as possible tumors. The reflected signals are directed to an image processing unit, which uses
an algorithm to generate a detailed map of the region (see infographic on the next page).
The system currently generates reconstructed two-dimensional images of the breast, but the hardware structure enables adjustments to the vertical position of the platform, allowing the antenna locations to be varied. The equipment can thus scan different sections of the breast, producing 3D images.
In tests on an artificial model, known as the phantom, with materials designed to replicate the electrical properties of mammary tissues, the device was found to detect tumors 1 cm in diameter at a depth of 3 cm, as detailed in a January 2023 article published in the journal Biomedical Signal Processing and Control
The internal structure of the phantom was also designed to simulate breast anatomy, with 0.2 cm of skin, 6 cm of glandular tissue, and 8.6 cm of fat tissue. Breast cancer is classified into four clinical stages according to its extent and severity. Tumors up to 2 cm in diameter that do not reach the lymph nodes are in the initial stage and are less severe.
X-ray mammography, which is recommended for the diagnosis of suspicious alterations at any age in both men and women, can identify lesions smaller than 1 cm, along with the initial signs of breast cancer, known as microcalcifications. “Currently, no other method identifies microcalcifications with the same accuracy,” says Bitencourt of the A.C. Camargo Center.
The microwave examination, although less accurate in its current version, may put a stop to the ionizing radiation used in traditional devices. “X-ray mammography needs shielded spaces, while the microwave-based technology does not emit ionizing radiation, making it safer and more accessible,” says electrical engineer Fatima Salete Correra, also of POLI-USP, who did not participate in the research. Low-cost, portable devices may provide benefits, particularly in regions where access to breast scans is more challenging. The team’s previous experience with the miniaturized integrated circuit known by the abbreviation SAMPA (serialized analog-digital multipurpose Asic), developed with the support of FAPESP, helped in the development of components for integration into the portable pro -
How the new scan works
The device is positioned at different angles around the breast to obtain the best possible image
1 The prototype uses a microwave transceiver with embedded antennae and a silicone rubber brassiere for dry coupling, with no need for conducting gel
The transceiver emits ultrabroadband radio waves, which pass through the mammary tissue and return to the device if they find denser internal structures
To generate a more comprehensive, clearer image, the device is positioned on different parts of the breast, without the need to compress it 2
totype. “Knowledge about how to design and build highly sensitive amplifiers, analog-digital converters, and signal processors was essential to our development of chips for use in health care,” explains Sanches, of the Polytechnic School. Created by researchers from USP, UNICAMP, and the Aeronautics Technology Institute (ITA), the SAMPA Chip has been in use since 2020 at one of the four particle detectors of the Large Hadron Collider (LHC), operated by the European Organization for Nuclear Research (CERN) on the French–Swiss border.
The next step for the São Paulo team will be to test the performance of the prototype on phantoms reflecting different breast sizes and tumor types. Companies have yet to show interest in collaborating on the project. In other countries, devices of this type are already in more advanced stages of development. In a review article published in December 2024 in IEEE Access, research-

4
A processing unit receives the reflected signals, and with the help of its own algorithm, it generates a two-dimensional map of the region examined
SOURCE BRUNO SANCHES (USP)
ers from USP and IFSP compared the performance of 12 prototypes and observed how they present different levels of sensitivity (ability to correctly identify the presence of a tumor) and specificity (ability to present a negative result with no tumor present).
Some demonstrated high levels of precision, such as the device at McMaster University, Canada, which was found to identify tumors of 2.4 mm, although the exam took five hours (see the infographic in the online version of this article). One of the most advanced devices, created at the University of Bristol in England, is known as Maria (multistatic array processing for radio-wave image acquisition). In a clinical trial involving 389 women with an average age of 47, the sixth version of the device correctly identified 47% of malignant lesions, which falls well short of the percentage for conventional mammography, whose correct identification rate was 92%, as detailed in the British Journal of Radiology in a January 2024 article.
Although the scan received positive evaluations from the women who underwent it, the authors of the study, led by radiologist Richard Sidebottom of the Royal Marsden NHS Foundation Trust, concluded that diagnosis by microwaves cannot yet be considered fully effective. Among the participants, 94% preferred this procedure to the traditional scan, primarily because there was no breast compression or ionizing radiation. Nine out of ten women reported greater comfort during diagnosis. l
Prototype of the microwave imaging system designed by USP and IFSP
The scientific articles consulted for this report are listed in the online version.
Aldebaran-I: The CubeSat designed at the UFMA is compact, measuring 10 cm on each side

To locate people lost at sea
A nanosatellite developed in Brazil is designed to help rescue small boats during maritime emergencies
YURI VASCONCELOS
Ananosatellite developed at the Federal University of Maranhão (UFMA), with support from the Brazilian Space Agency (AEB), may assist coastal authorities in search and rescue operations for small fishing boats in distress. The device, a standard 1U CubeSat with a cubic shape measuring 10 centimeters (cm) per side, will also be used to detect wildfires.
Five years after the project began, the satellite—named Aldebaran-I—underwent final testing in January. “One of the key tests was vibration, which ensures the satellite can withstand the extreme launch conditions,” says aeronautical engineer Carlos Alberto Brito Rios Junior, professor of aerospace engineering
at UFMA and the project’s coordinator. “The satellite is now ready to be shipped to India, where it will be launched into orbit.” The launch is scheduled for June.
The name Aldebaran-I refers to the brightest star in the constellation Taurus. “The word has Arabic roots and means ‘the follower,’ which relates to the satellite’s mission. At the same time, some say Aldebaran is the star that sits on the forehead of the ox—the central figure in Maranhão State’s most traditional festival, Bumba Meu Boi ,” explains Brito.
The project is part of an initiative under the National Space Activities Program, which focuses on developing academic nanosatellites—low-cost devices with shorter development cycles. “We have several satellite projects underway in Brazil, some led by government research centers, others by private companies, and a group being developed by universities,” says Rodrigo Leonardi, Portfolio Management Director at AEB. In addition to advancing technological development, Leonardi notes that the nanosatellite program is also intended to train skilled professionals for the space sector and to build technical capacity within Brazilian universities.
These nanosatellites serve a range of purposes, including Earth observation, scientific research, and the development of new space technologies. “Nanosatellites and CubeSats were originally created for educational purposes,” notes a 2020 article by researchers from the

National Institute for Space Research (INPE), published in the journal Ambiente & Água. “Although still in the early stages, nanosatellite applications and proposed missions are expanding.”
UFMA’s nanosatellite serves as a proof of concept. Its mission is to validate a new technology. Small fishing boats will be equipped with a transmission system that sends their location data to the satellite. “These signals will be relayed to a ground station, which will then dispatch an emergency alert to rescue services,” explains Dr. Luís Claudio de Oliveira Silva, an engineer and head of UFMA’s Laboratory of Electronics and Embedded Space Systems (LABESEE), where the project was developed.
For fire prevention, data collection platforms installed in forested areas will transmit information to the satellite, which will then forward it to a ground station. “An AI-based system will analyze the data to detect potential fire indicators,” explains Silva.
If Aldebaran-I proves successful, building a constellation of nanosatellites will be essential to fully implement rescue and fire monitoring services. “Only with a constellation can we ensure continuous satellite coverage over Brazil,” says Leonardi. “We’re exploring the development of small satellite constellations. If this proof of concept succeeds, it could lead to a system of this kind.” l
The scientific article consulted for this report is available in the online version.

A national voice
New studies revisit the legacy of Jorge Amado, revealing an author deeply engaged with racial, class, and gender issues
EDUARDO MAGOSSI

Jorge Amado in 1972: Although translated into 49 languages, his books never achieved universal critical acclaim in Brazil
“D
ona Flor: This character is coming along nicely. The last two scenes I churned out quickly—the first in a day, although the second took me four: it was the scene of Vadinho’s arrival, after all. I’ve now started on part five. Today I’m tackling the first scene. It’s in rough form—needs rewriting. This fifth section is proving difficult.” That’s how celebrated Bahian author Jorge Amado (1912–2001) described his effort in crafting a pivotal scene from Dona Flor and her two husbands (1966) in a 1962 letter to his wife, fellow writer Zélia Gattai (1916–2008). “At first glance, Amado’s prolific body of work might suggest he was a haphazard writer who didn’t dwell on craft,” says Marcos Antonio de Moraes, a professor of Brazilian literature at the University of São Paulo (USP). “But his correspondence tells a different story: Amado was methodical, allowed his ideas time to mature, and often anguished over his writing as a work in progress.”
Moraes is one of 56 contributors to the newly published Dicionário crítico Jorge Amado (A critical dictionary of Jorge Amado; EDUSP), edited by historians Marcos Silva (1950–2024), formerly of USP’s School of Philosophy, Languages and Literature, and Human Sciences (FFLCH), and Nelson Tomelin Jr. of the Federal University of Amazonas (UFAM). Ten years in the making, the book is a collection of essays on Amado’s oeuvre written by scholars from various disciplines, including literary studies and anthropology. Among other works, it explores Amado’s 23 novels written since the 1930s—titles such as Jubiabá (1935) and Gabriela, clove and cinnamon (1958). It also includes entries on moments that shaped Amado’s trajectory, such as his 1961 induction speech at the Brazilian Academy of Letters.
According to Tomelin Jr., one of the aims of the publication, which was produced with support from the Amazonas State Research Foundation (FAPEAM), is to help expand and refresh the public’s understanding of Amado’s work and its historical context. “Amado has an enormous readership in Brazil and abroad, due in large part to the vitality of his prose, the thematic reach of
his novels, and their resonance with the times in which they were written. But the critical reception in Brazil has often been mixed,” notes the researcher. One possible reason, suggests Eduardo de Assis Duarte, professor emeritus at the School of Languages and Literature at the Federal University of Minas Gerais (UFMG), is precisely Amado’s immense popularity with readers. “Some in academia dismiss him as a ‘lightweight’ author of serialized fiction,” Duarte says, “but as early as the 1930s, he was already tackling weighty national issues—like youth homelessness in Captains of the sands [1937].”
According to journalist and historian Joselia Aguiar, author of Jorge Amado: Uma biografia (Jorge Amado: A biography; Todavia, 2018), critical engagement with Amado’s work began in the 1930s. “In his early years, Amado enjoyed strong critical acclaim, drawing praise from names like Oswald de Andrade [1890–1954] and Antonio Candido [1918–2017],” says Aguiar, who earned her Ph.D. in 2019 at the University of São Paulo’s Department of History, where she wrote her thesis on the Brazilian author. “That changed in the 1970s,” she explains. “Critics increasingly approached his work through a gender lens. One notable example was Walnice Nogueira Galvão’s critique of Tereza Batista: Home from the wars (1972), which cast the novel in a negative light and shaped academic opinion thereafter.”
Aguiar notes that as Brazil’s Black movement gained momentum in the late 1970s, authors such as Amado—who touched on racial themes—came under fire for portraying race relations in a way that some viewed as overly conciliatory. “Today, though, even in these critical arenas, his work is being revisited and reassessed,” Aguiar says. This return has been fueled in part by a growing number of Black students entering Brazilian universities over the past 25 years, bringing new perspectives into academia. Another key factor is the republishing of Amado’s work by Companhia das Letras beginning in 2008. “What’s still lacking,” she adds, “is more engagement from within the literary field itself—a closer look at what made his work so successful and the mechanics of his storytelling.”
Another recurring critique—raised by literary scholars such as Alfredo Bosi (1936–2021) of USP—is that some of Amado’s early works, especially from the 1930s to the 1950s, leaned too heavily into political propaganda. After joining the Brazilian Communist Party (PCB) in 1931, Amado began writing overtly ideological texts— books and pamphlets commissioned by the party—many of which were never reprinted. A prime example is Homens e coisas do Partido Comunista (Men and things of the Communist Party; 1946), which is part of a series published by Horizonte, a publishing house run by the PCB. In 61 pages, the book tells the story of communist activists portrayed as heroes in the fight against fascism during Brazil’s Estado Novo regime (1937–1945).
“This ideological phase of Amado’s career is often criticized not just for its communist alignment, but for how he became a de facto party propagandist—promoting international socialism through the framework of socialist realism,” says Lincoln Secco of FFLCH-USP, who authored the dictionary entry on Homens e coisas do Partido Comunista. Despite alienating literary critics, these partisan works propelled Amado to international prominence. His biographical novel The Knight of Hope (1942), written at the party’s request and chronicling the life of leftist leader Luís Carlos Prestes (1898–1990), was translated into 21 languages, including German, French, and Japanese. “The Communist movement invested heavily in publishing to promote its causes,” notes Secco.
In a 2024 doctoral thesis defended at FFLCHUSP, aided by research grant funding from FAPESP, historian Geferson Santana explored how Amado, along with fellow Bahian intellectuals Edison Carneiro (1912–1972) and Aydano do Couto Ferraz (1914–1985), engaged in debates on race and class in early twentieth-century Brazil.
“In the 1920s, the PCB denied that racism existed in Brazil—and even embraced the notion of racial whitening,” Santana explains. “The three intellectuals, who joined the party in the 1930s, were among the key figures who pushed the PCB to take up racial issues,” he says. “Their goals included fighting racism and religious intolerance, and increasing Black workers’ representation within the party.”
Amado’s overtly political literary phase extended into the 1950s. His final ideological work is widely regarded to be the trilogy The bowels of liberty (1954), written during his exile in Europe. The trilogy’s three volumes— Bitter times, agony of night, and Light at the end of the tunnel paint a sweeping portrait of Brazilian political life just before the 1937 coup led by Getúlio Vargas. According to Antonio Dimas, a professor of Brazilian literature at FFLCH-USP, the trilogy reads like Amado’s final tribute to the Communist Party—his way of closing a chapter before leaving the party in 1956. “It’s as if he were saying: ‘This trilogy is my discharge—my dues paid in full,’” says Dimas.
Many scholars, including Dimas, point to Gabriela, Clove and Cinnamon (1958) as a watershed moment in Jorge Amado’s literary career. He sees this work as the moment Amado left political propaganda behind to become a pure novelist. “This was a different Amado—with more humor and irony. After Gabriela, he would go on to create unforgettable heroines like Tieta and Dona Flor,” says Dimas. “But it’s worth noting,” he adds, “that even in The Country of Carnival [1931], which he wrote at 18, women already appear as strong and resilient—even when they’re relegated to the margins of the story.”



On the left, from left to right: Zélia Gattai, philosophers Jean-Paul Sartre and Simone de Beauvoir, and Jorge Amado with Mãe Senhora (seated ) in Salvador, 1960s. Above: Covers of Jubiabá and the U.S. edition of Gabriela, clove and cinnamon


Eduardo de Assis Duarte of UFMG, however, sees no sharp rupture in Amado’s literary trajectory. He makes this case in his new book, Narrador do Brasil: Jorge Amado, leitor de seu tempo e de seu país (Jorge Amado: Narrator of his time and nation; Fino Traço Editora, 2024). In Duarte’s view, Amado consistently explored the themes of gender, class, and race throughout his literary career. “He always wrote about free women, in charge of their own lives,” says Duarte. “He went so far as to place two sex workers at the center of his stories—Tieta [1977] and Tereza Batista: Home from the wars.”
Owing to works such as Gabriela, clove and cinnamon , Jorge Amado earned a spot in the Guinness World Records in 1996 as the world’s most translated author. His works have been translated into 49 languages. Amado’s novels began reaching U.S. readers in the 1940s, owing largely to President Franklin D. Roosevelt’s (1892–1945) Good Neighbor Policy, a diplomatic strategy launched after World War II (1939–1945). As part of that policy, the U.S. State Department
sponsored efforts to publish international authors in the U.S. market.
Amado made his American debut with The violent land , published in Brazil in 1943 and translated into English in 1945. The English edition was published by American publishers Alfred Knopf (1892–1984) and his wife Blanche Knopf (1894–1966). “In their publishing under the Good Neighbor Policy, the Knopfs were especially drawn to authors whose fiction shed light on Brazilian history,” explains Marly Tooge, a translator who published an article on the topic in 2024. “That included not just Amado, but also Érico Verissimo [1905–1975].”
After Gabriela was published in the United States in 1962, Jorge Amado landed on The New York Times best-seller list—where he stayed for a full year. “It would seem that Amado’s departure from Marxist ideology in the 1950s helped pave the way for his success in the U.S.,” says Tooge. “But it also had to do with the way his books were translated.” Her 2009 master’s thesis at FFLCH-USP was later turned into the FAPESP-funded book Traduzindo o BraZil: O país mestiço de Jorge Amado (Translated as BraZil: Jorge Amado’s mixed-race nation; Humanitas, 2012). She notes how translators James Taylor and William Grossman softened the novel’s social critique in English and amplified its sensual appeal. “This kind of sanitization was also done with other Amado novels published in the U.S., like Dona Flor and her two husbands,” she adds. “Publishers placed an emphasis on the ‘exotic’ side of his stories in marketing campaigns. In contrast, Amado’s ideological works saw more success in Europe.”
Beyond fiction, Amado was also a prolific correspondent. Joselia Aguiar notes how the archive of letters compiled by Amado and his wife Zélia Gattai—which is now preserved at the Jorge Amado Foundation in Salvador—holds approximately 70,000 letters. In her doctoral thesis, Aguiar focused on Amado’s correspondence between the 1950s and 1980s with Spanish-language authors such as Cuban poet Nicolás Guillén (1890–1954) and Chilean Nobel laureate Pablo Neruda (1904–1973). “Through these letters, Amado built a network of both emotional and cultural-political camaraderie. He saw literature in Latin America as a tool of resistance to imperialism,” says Aguiar. “He believed it was essential to discover and express a truly national voice through literature.” l
The research project, scientific article, and books consulted for this report are listed in the online version.
From top: Two photos of Amado (standing) from the 1960s—first, at a gathering attended by President João Goulart (to the left of the lamp), and second, at the Brazilian Academy of Letters

The bars of time
Research finds rarities and widens access to little-known musical archives
EDUARDO MAGOSSI
Rio de Janeiro was one of the first cities outside Europe to witness a performance of Requiem by Wolfgang Amadeus Mozart (1756–1791).
In 1819, the city hosted a presentation of the funeral mass penned by the Austrian composer in 1791, according to a study by musicologist Ayres de Andrade Júnior (1903–1974) published in the 1960s. The piece was also performed in São Paulo during the first half of the nineteenth century, according to recent research coordinated by musicologist Paulo Castagna of the Institute of Arts at São Paulo State University (UNESP), São Paulo City campus.
Over the past three years—two of them funded by FAPESP—the researcher and his team cataloged and organized the entire musical archive (i.e., scores) from the old São Paulo Dramatic and Musical Conservatory Library, a space that functioned between 1906 and 2006 in the downtown area of the state capital, which today is home to the Praça das Artes (Plaza of the Arts).
The manuscript copy of the Requiem sheet music was among the items retrieved through the research. Although undated, the document was copied by the master of the São Paulo Cathedral Chapel, Antônio José de Almeida (1816–1876), who occupied his post in the 1840s. “It is estimated that the copy was made around 1850,” says Castagna. “This work was expensive and time-intensive in that era. To make a copy and not perform it would be a waste. It is therefore very probable that it was performed.”
In total, Castagna and his team cataloged approximately 17,000 items from the musical archives of the old conservatory, which today belongs to the São Paulo Municipal Theater Foundation. It is the third-largest collection of its genre in
Brazil, after the National Library (Rio de Janeiro) and the Alberto Nepomuceno Library of the Federal University of Rio de Janeiro (UFRJ). “It is an important collection due to its chronological and stylistic diversity, with works composed in Brazil and overseas between the eighteenth and twentieth centuries, ranging from opera and sacred pieces to band compositions and popular music,” explains the researcher.
According to Castagna, although the collection comprised material purchased by the conservatory, the institution also received several donations, such as the personal archives of four composers and former professors at the institution: João Pedro Gomes Cardim (1832–1918), Carlos de Campos (1866–1927), João Gomes de Araújo (1846–1943), and João Gomes Junior (1868–1963). “They are little-known composers, with no recent editions or recordings,” says Castagna. “Cardim, for example, crafted the Hino da Abolição (Abolition Hymn) in 1881 for performances to raise funds for the campaigns of abolitionist Luís Gama [1830–1882].”
The researcher and his team discovered at least 275 original works by the four men. In March, nine pieces composed by Gomes de Araújo for either solo piano or singing and piano were performed during an event in the auditorium of the UNESP Institute of Arts. “The idea is to make this material available for research, interpretation, and recording.”
The project also discovered two works by music professor Presciliano Silva (1847–1897): Missa a 4 vozes e pequena orquestra, op. 17 es and small orchestra, op. 17), and piece for fiddle and piano. “He was one of the first Black professors in the São Paulo State education al system and started work in 1891 at the Normal School, now known as the Caetano de Campos State School in the city’s downtown area,” adds
Manuscript copy of the score for Requiem (right On the other page, a score composed by Carlos de Campos, former professor of the São Paulo Dramatic and Musical Conservatory

Castagna. “The newspapers of that time carry stories that these two compositions were performed to much applause across several Brazilian cities.”
Another researcher seeking to spread the word on works deposited in the archives is musicologist Tadeu Moraes Taffarello, of the Center for the Documentation of Contemporaneous Music at the University of Campinas (CDMC-UNICAMP). Since 2021, he has been organizing and editing rare sheet music by composers such as José Antonio Rezende de Almeida Prado (1943–2010) and Dinorá de Carvalho (1895–1980), deposited at the CDMC. With support from FAPESP, Taffarello reviews, digitalizes, and publishes sheet music in free-to-download e-books. This material also provides information on the works and composers and the editing process.
Created in 1989 by UNICAMP and the Centre de Documentation de la Musique Contemporaine, in France, the Brazilian CDMC received from its French counterpart sheet music and musical recordings of the twentieth century from different parts of the world.
“From this overseas exchange came a lot of sheet music and recordings on cassette tape that we are in the last stages of digitalizing,” says Taffarello. The partnership terminated 10 years later.
Today, the CDMC also holds an archive of Brazilian classical music from the twentieth and twenty-first centuries. “Among others, we hold donated personal archives, such as the collection of works by composer Almeida Prado,” he explains. A student of composer and conductor Camargo Guarnieri (1907–1993) and pianist Dinorá de Carvalho, Prado was a professor at UNICAMP between 1975 and 2000 and left more than 570 compositions.

Among other accomplishments, Carvalho founded the Women’s Orchestra of São Paulo, whose first public performance took place in 1940. Their material was also donated to the CDMC. Taffarello recalls that to mark the birth centenary of the pianist in 1995, friends and musical colleagues decided to honor her, and they appealed to anyone in possession of scores composed by the musician to donate them to UNICAMP for a collection of her work there.
Taffarello has published 12 e-books to date. The next, which is scheduled to be released this semester, will be the sheet music for Manhã radiosa (Radiant morning) by Carvalho. In a preprint article (not yet peer-reviewed) in 2025, Taffarello, pianist and composer Vitor Alves de Mello Lopes, and CDMC librarian Raquel de Souza observed that the piece for solo piano Lá vae a barquinha carregada de? (There goes the little boat loaded with?), published in 1939 by Editora Casa Wagner, was released two years later under the same title and in a simplified version by publishing house Ricordi Brasileira. Even after these two publications, the composer continued to work on the piece and created other versions until finalizing Manhã radiosa, officially released in 1946. “Dinorá’s compositional practice is characterized by construction, which often spends years in creation, with different versions of the same piece,” says Taffarello.
It is not always easy to edit the scores. “As in the case of Dinorá, there are often several versions of a composition,” highlights Taffarello. The CDMC partners with the UNICAMP Symphony Orchestra, led by principal conductor Cinthia Alireti, which performs these works in its concerts. This partnership helps to enhance the final result of editing, according to the researcher.
Another challenge is finding the complete scores for production of the e-book, which is now in the final stages of editing, about the theater piece Noite de São Paulo (A São Paulo Night) (1936)

Below, historian Rafael Araújo of the São Paulo Municipal Theater Foundation carefully handles sheet music cataloged by Paulo Castagna and his team from UNESP


by playwright Alfredo Mesquita (1907–1986), musically scored by Carvalho. The orchestral sheet music was missing for the song Bamboleia, which, at the time, was held by the Mário de Andrade fund of the University of São Paulo’s Brazilian Studies Institute (IEB-USP). The collection is made up of books, scores, manuscripts, records, and other documents produced by the São Paulo-Stateborn writer, critic, and musicologist. “Dinorá was a contemporary of Mário de Andrade [1893–1945], to whom he dedicated many of his compositions. It’s likely that he himself gave the scoresheet to his friend as a present,” says musicologist Flávia Toni of IEB-USP, a specialist on the canon of Andrade.
One of Toni’s tasks was to organize Andrade’s discography archive in 1985 as part of a project coordinated by researcher Telê Ancona Lopez of USP, supported by FAPESP. A professor at the São Paulo Dramatic and Musical Conservatory, he would note his listening impressions on plain cardboard covers that replaced the original factory record sleeves. These notes were contextualized by letters and articles and led to the 2004 book Popular Brazilian music on the turntable of Mário de Andrade, recently reedited by Edições Sesc in an extended, revised version. Caraça College, which operated between 1820 and 1842 in the state of Minas Gerais, and the Imperial Music Conservatory, which was founded in Rio de Janeiro in 1848, feature some of the first musical archive repositories in Brazil. According to Castagna, the states of São Paulo and Minas Gerais are currently home to the greatest number of these collections—63 and 57, respectively— with a predominance of sacred and band music.
Musicologist Fernando Lacerda Duarte of the Federal University of Pará (UFPA) has visited 225 cities in Brazil in search of these archives, primarily in search of sacred music. “They generally need

treatment; I once found a collection that included, among other items, sheet music in the roof space of the Belém Cathedral. Sometimes, management changes in a certain parish mean that the archive is discarded, music included,” he says.
Lacerda’s field research has revealed that local language has been used in Catholic hymns in Brazil since the nineteenth century. The Vatican officially allowed only masses and hymns to be sung in Latin, with the use of local languages formally permitted only after the Second Vatican Council (1962–1965). “In Brazil, the local or vernacular language has been used continuously since at least the 1860s,” says the researcher. “As the Church prohibited singing in [the] vernacular, these hymns appeared as popular or traditional melodies, a more efficient way of spreading the gospel.”
Sheet music is not the only source of music history research. In the archive of German Uruguayan musicologist Curt Lange (1903–1997), the letters are the key feature, explains musicologist Edite Rocha, coordinator of the space, which has been housed at the Federal University of Minas Gerais (UFMG) since its inception in 1995. Among records and photographs, there are more than 100,000 pieces of correspondence representing exchanges between Lange and researchers, intellectuals, politicians, and institutions between the 1920s and 1990s.
Starting with his time in Minas Gerais between 1944 and 1945, Lange produced a very large inventory of scores and manuscripts that became one of the world’s key sources of Brazilian music. “Lange organized all the letters he received and also kept a copy of those he sent,” explains Rocha, a professor at the UFMG School of Music. “His correspondence, with lots of stories from backstage, makes him an essential figure for researchers interested in the music and musicology of Brazil and Latin America in the twentieth century.” l
At the piano, Dinorá de Carvalho in the 1920s, and musicologist Curt Lange (fourth from the left) in 1934, at a gathering in Rio de Janeiro, with guests including Mário de Andrade (in white)
photolab knowledge in images

Backward Roland Garros
It looks like a tennis ball on a clay court, but it is actually a microstructure that can be used as a basis for producing refractory ceramics. When viewed under an electron microscope, what appears to be a sphere is actually a cavity. The matrix of the material is composed of magnesium oxide, with the precipitation of the mineral spinel. The image, obtained during a study aimed at producing sustainable alternatives to aggregates containing chromium—which is toxic to humans and the environment in soluble form—won an award at the international conference of the American Ceramic Society in October.
Image submitted by materials engineer Otávio Henrique Borges , a doctoral student at the Federal University of São Carlos (UFSCar), obtained in partnership with his advisor, Victor Carlos Pandolfelli
PRESIDENT
Marco Antonio Zago
VICE-PRESIDENT Carmino Antonio de Souza
BOARD OF TRUSTEES Antonio José de Almeida Meirelles, Carlos Gilberto Carlotti Junior, Felipe Ferreira Guimarães Figueiredo, Franklim Shunjiro Nishimura, Helena Bonciani Nader, Herman Jacobus Cornelis Voorwald, Marcílio Alves, Maria Arminda do Nascimento Arruda, Pedro Wongtschowski, Thelma Krug
EXECUTIVE BOARD
EXECUTIVE DIRECTOR
Carlos Frederico de Oliveira Graeff
SCIENTIFIC DIRECTOR
Marcio de Castro Silva Filho
DMINISTRATIVE DIRECTOR
Fernando Menezes de Almeida
pesquisafapesp
ISSN 1519-8774
SCIENTIFIC COMMITTEE
Luiz Roberto Giorgetti de Britto (President), Ana Claudia Latronico, Ana Claudia Torrecilhas, Ana Cristina Gales, Ana Maria Fonseca de Almeida, Carlos Frederico de Oliveira Graeff, Daniel Scherer Moura, Dario Simões Zamboni, Deisy de Souza, Douglas Zampieri, Eduardo Magalhães Rego, Eduardo Zancul, Fabiana Cristina Komesu, Fernando Menezes de Almeida, Flávio Henrique da Silva, Gustavo Dalpian, Helena Lage Ferreira, João Pereira Leite, José Roberto de França Arruda, Lício Augusto Velloso, Liliam Sanchez Carrete, Luiz Nunes de Oliveira, Luiz Vitor de Souza Filho, Marcio de Castro Silva Filho, Marco Antonio Zago, Mariana Cabral de Oliveira, Marta Arretche, Michelle Ratton Sanchez Badin, Nina Stocco Ranieri, Paulo Schor, Richard Charles Garratt, Rodolfo Jardim Azevedo, Sergio Costa Oliveira, Sidney José Lima Ribeiro, Sylvio Canuto, Vilson Rosa de Almeida
SCIENTIFIC COORDINATOR
Luiz Roberto Giorgetti de Britto
EDITOR-IN-CHIEF Alexandra Ozorio de Almeida
EDITOR
MANAGING
Neldson Marcolin
EDITORS
Fabrício Marques (S&TPolicy) Carlos Fioravanti (Earth sciences) Marcos Pivetta (Exact sciences) Maria Guimarães (Biological sciences) Ricardo Zorzetto (Biomedical Sciences) Yuri Vasconcelos (Technology)
Ana Paula Orlandi (Humanities) and Christina Queiroz ( Assistant editor)
REPORTER
Sarah Schmidt
ART
Claudia Warrak (Editor)
Júlia Cherem Rodrigues and Maria Cecilia Felli (Designers) Alexandre Affonso (Infographics editor)
PHOTOGRAPHER
Léo Ramos Chaves
IMAGE DATABASE
Valter Rodrigues
TRANSLATORS
Ricardo Lay (coordination & review), Tom Jamieson, Peter Hunrichs, Tiago Barnavelt, Jack Martin, Nancy Berube Lang, Mark Thompson
CONTRIBUTORS
Danilo Albergaria, Eduardo Magossi, Gilberto Stam, Giselle Soares, Otávio Henrique Borges, Renata Fontanetto
PRINTER
Elyon Soluções Gráficas
THE REPRINTING OF TEXTS, PHOTOS, ILLUSTRATIONS AND INFOGRAPHICS IN WHOLE OR IN PART, IS PROHIBITED WITHOUT PRIOR AUTHORIZATION
ADMINISTRATIVE MANAGEMENT FUSP – FUNDAÇÃO DE APOIO À UNIVERSIDADE DE SÃO PAULO
PESQUISA FAPESP
Rua Joaquim Antunes, nº 727, 10º piso
CEP 05415-012, São Paulo, SP, Brasil
FAPESP
Rua Pio XI, nº 1.500
CEP 05468-901, São Paulo, SP, Brasil
Department for Economic Development, Science And Technology
SÃO PAULO STATE GOVERNMENT


